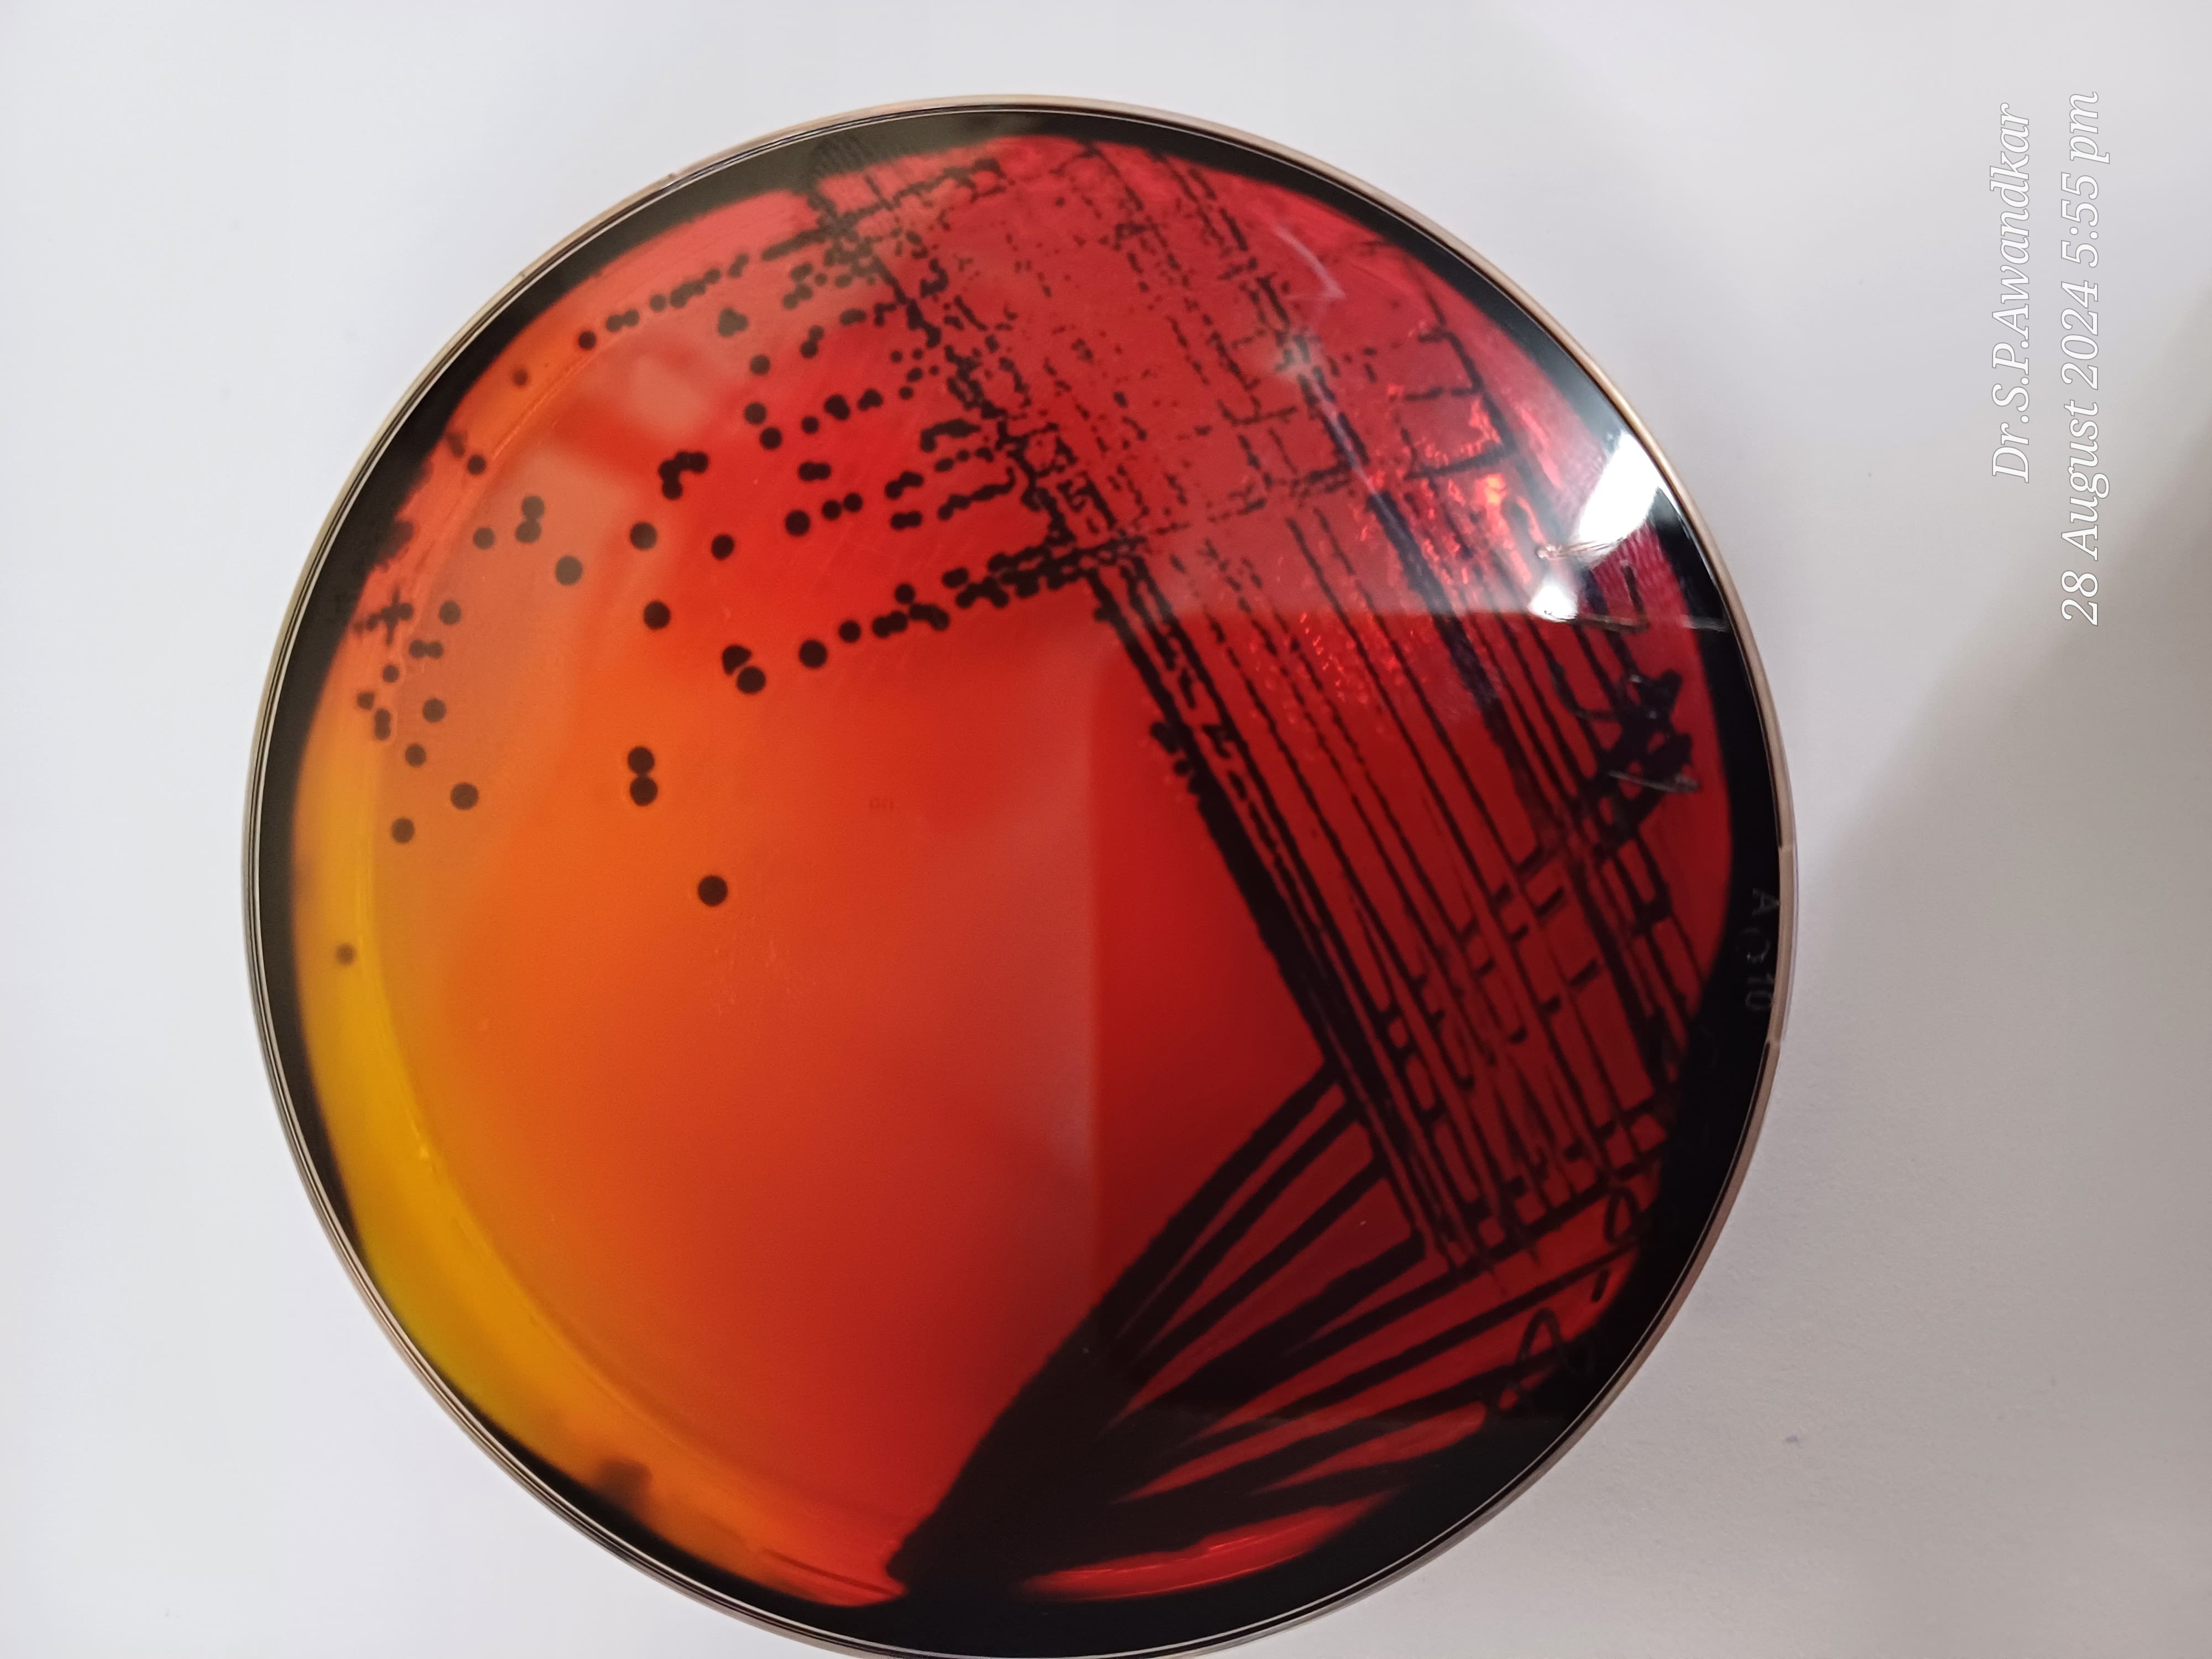
13. Salmonella Typhimurium
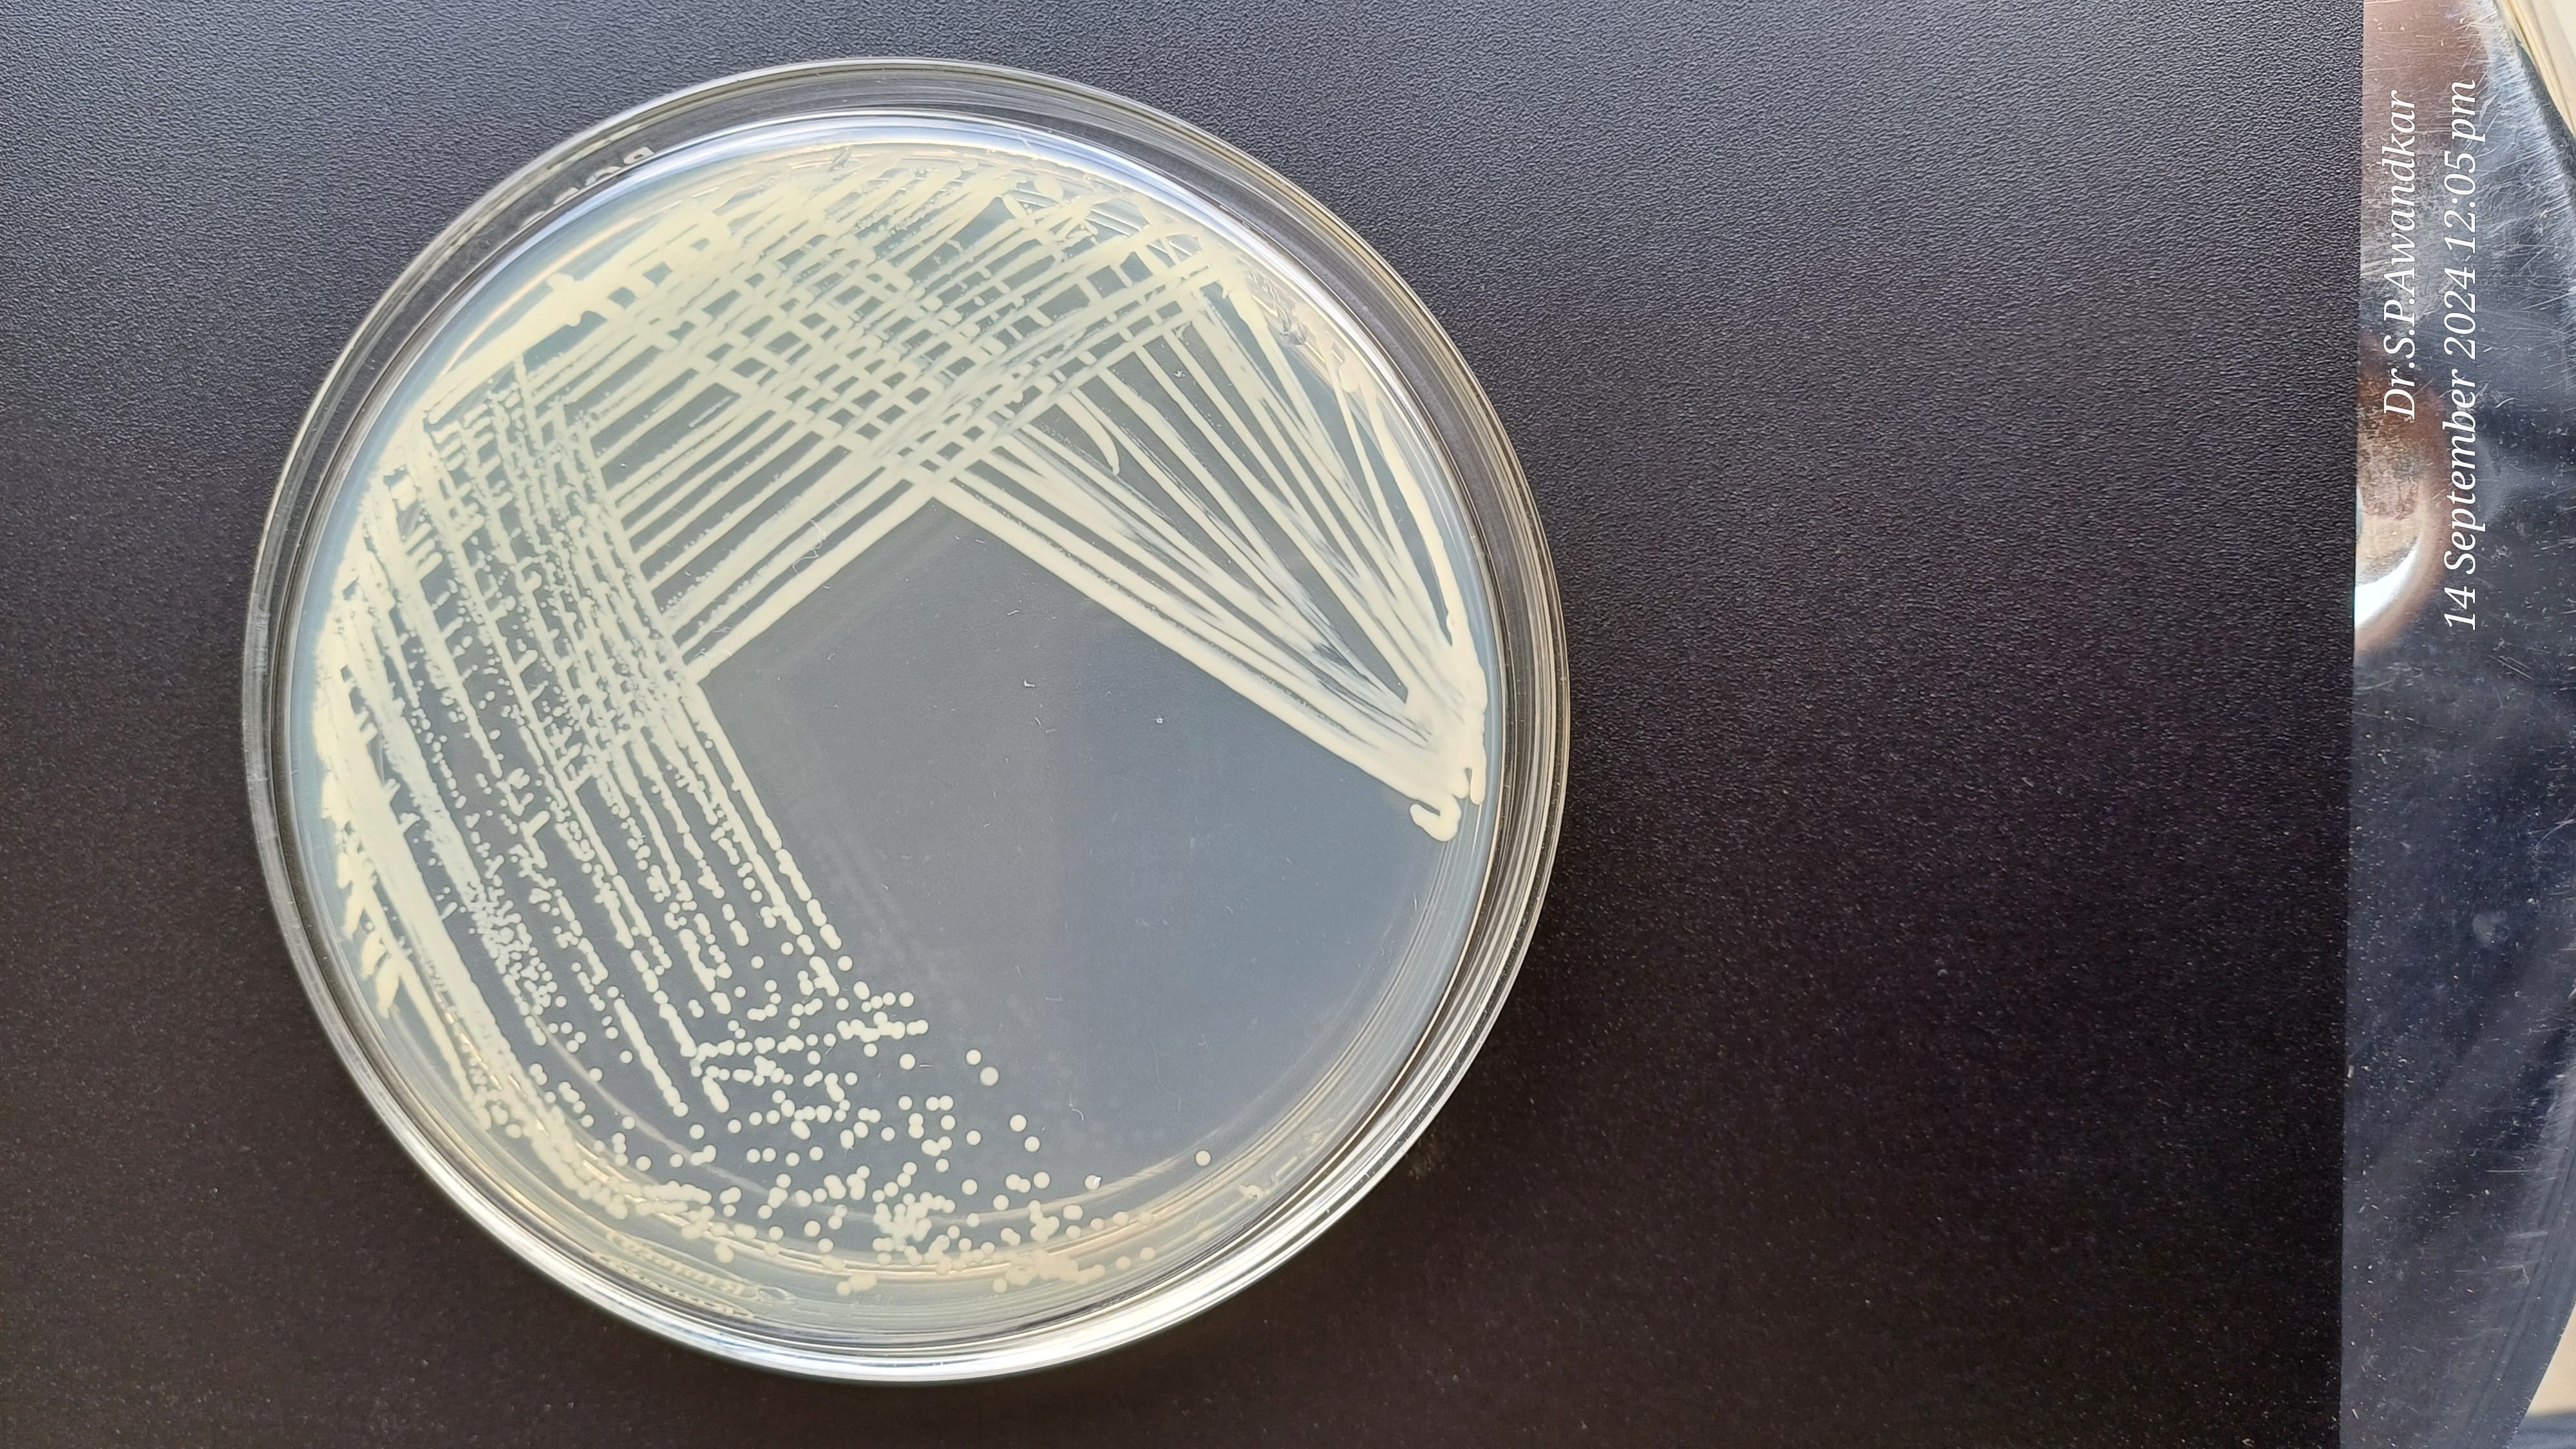
15. Diplococci Spp.
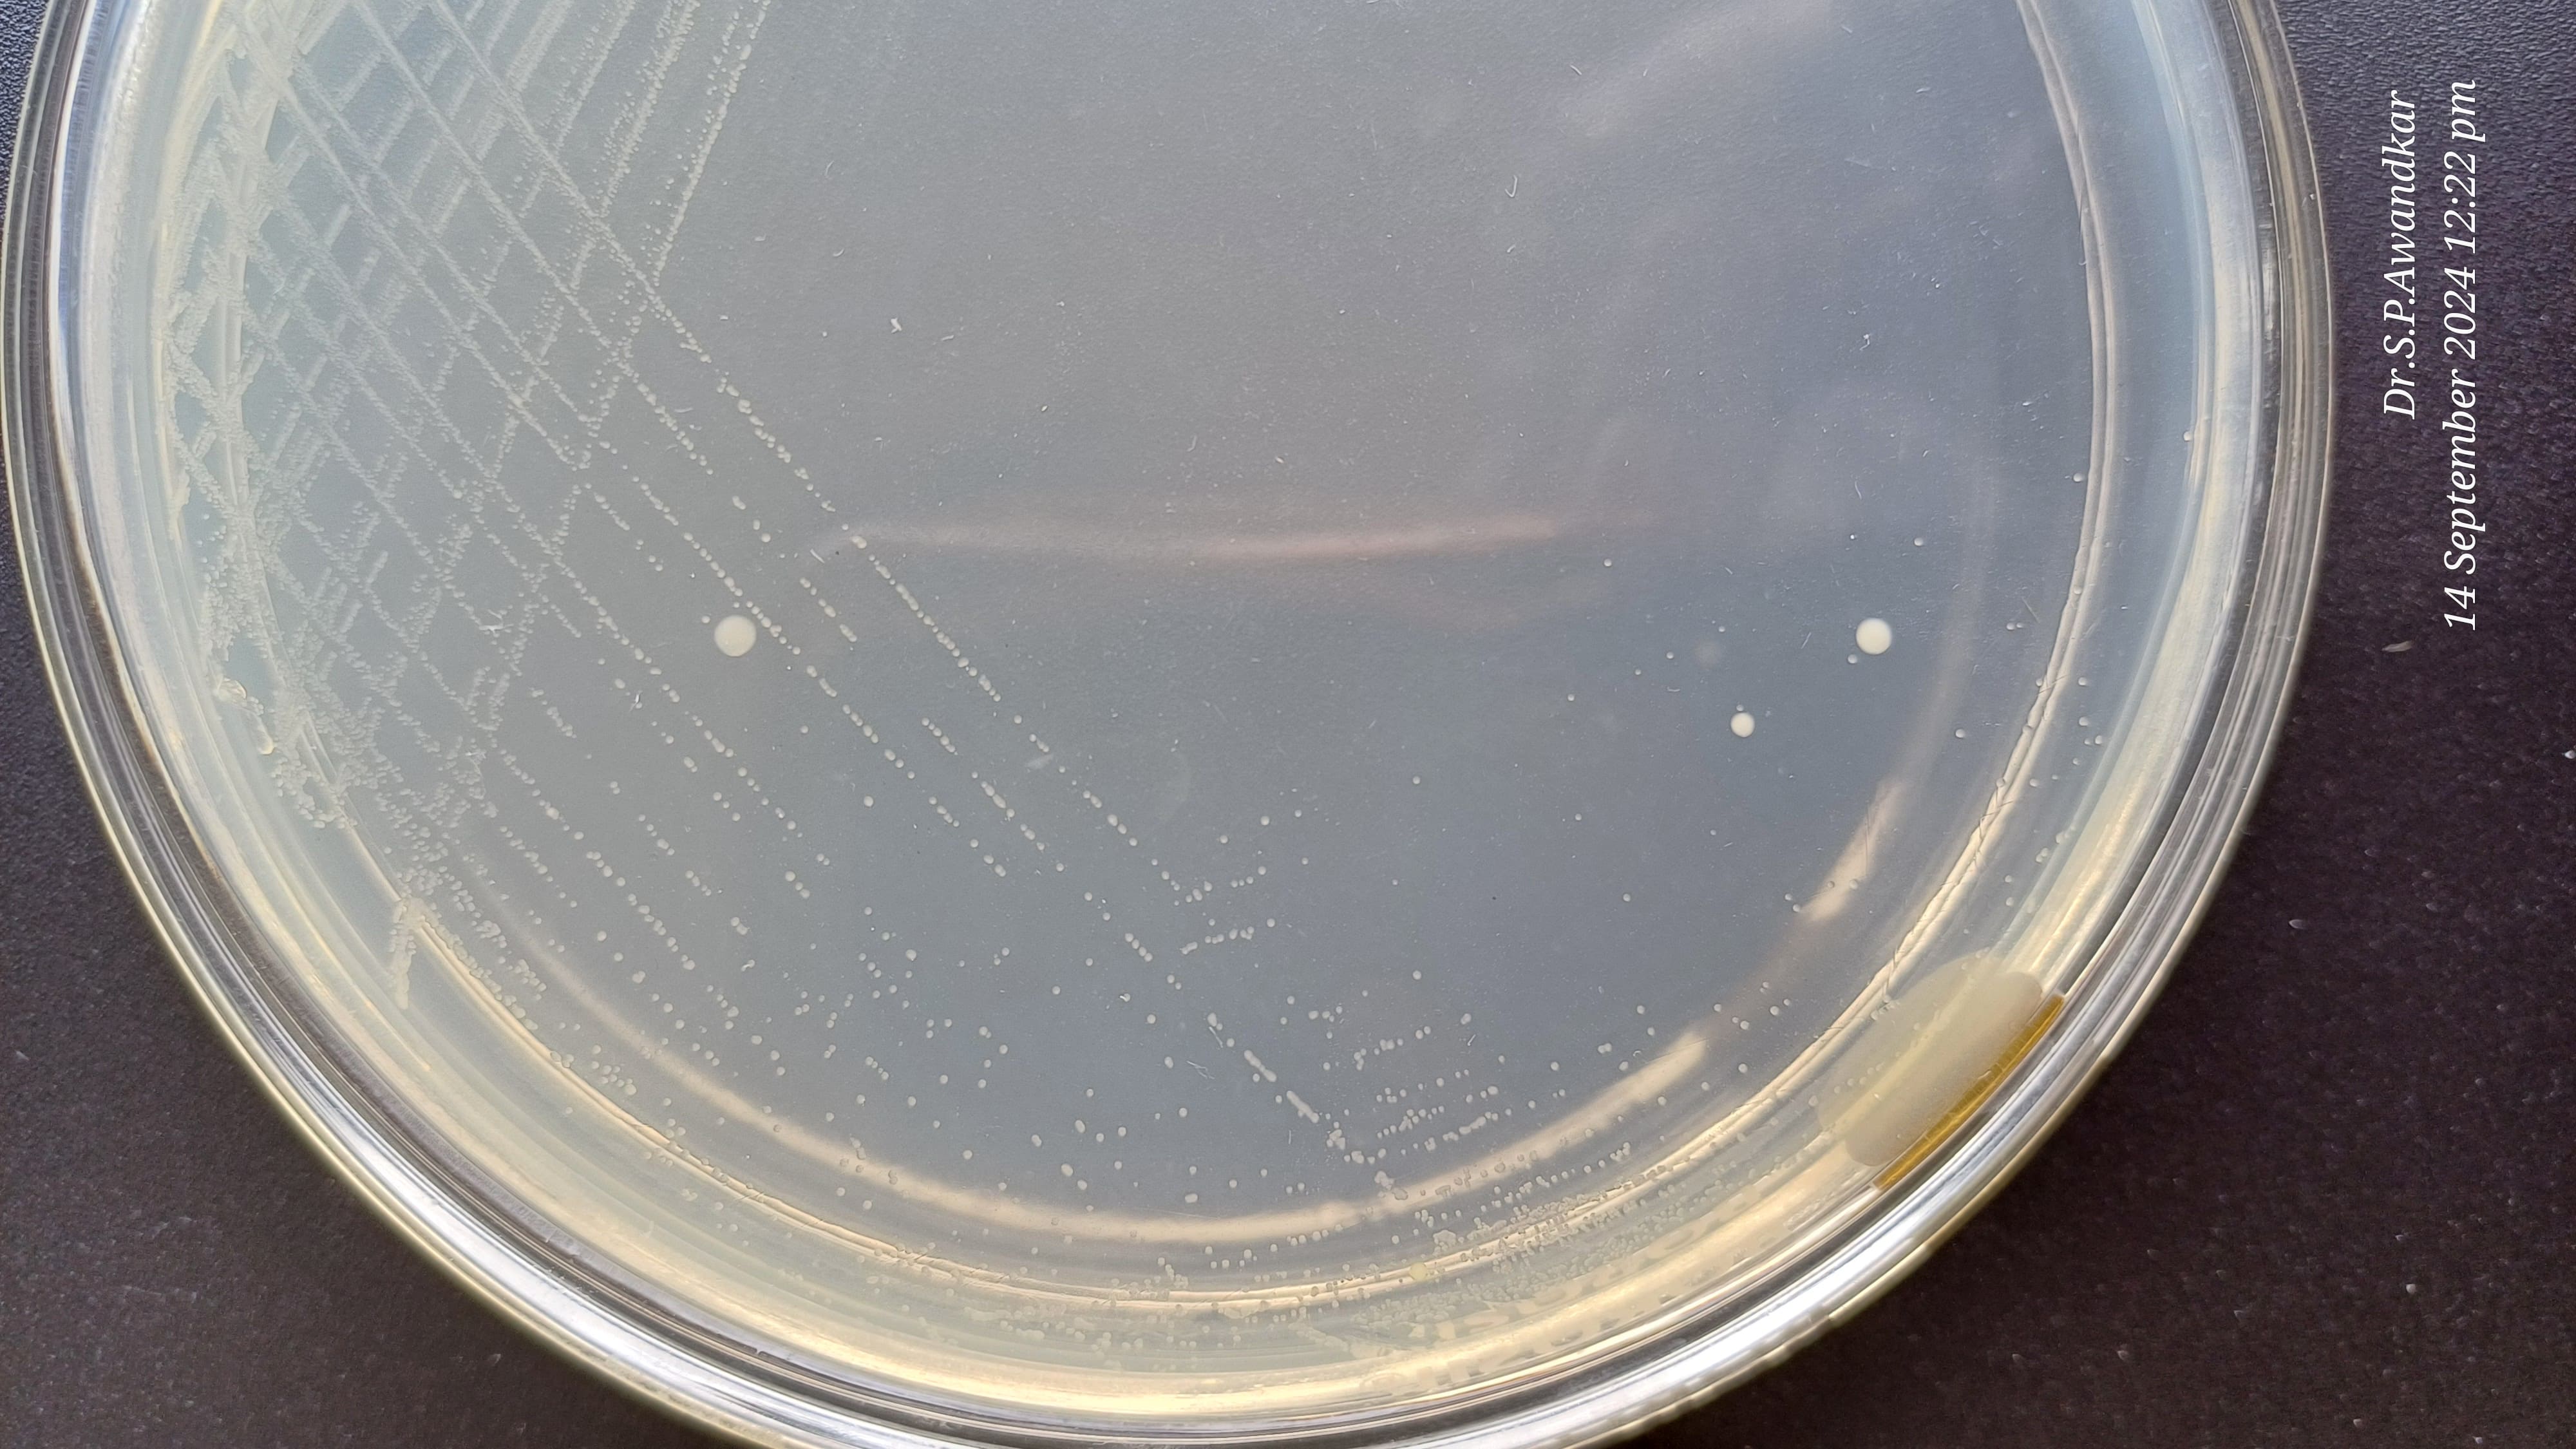
16. Streptococcus Spp.
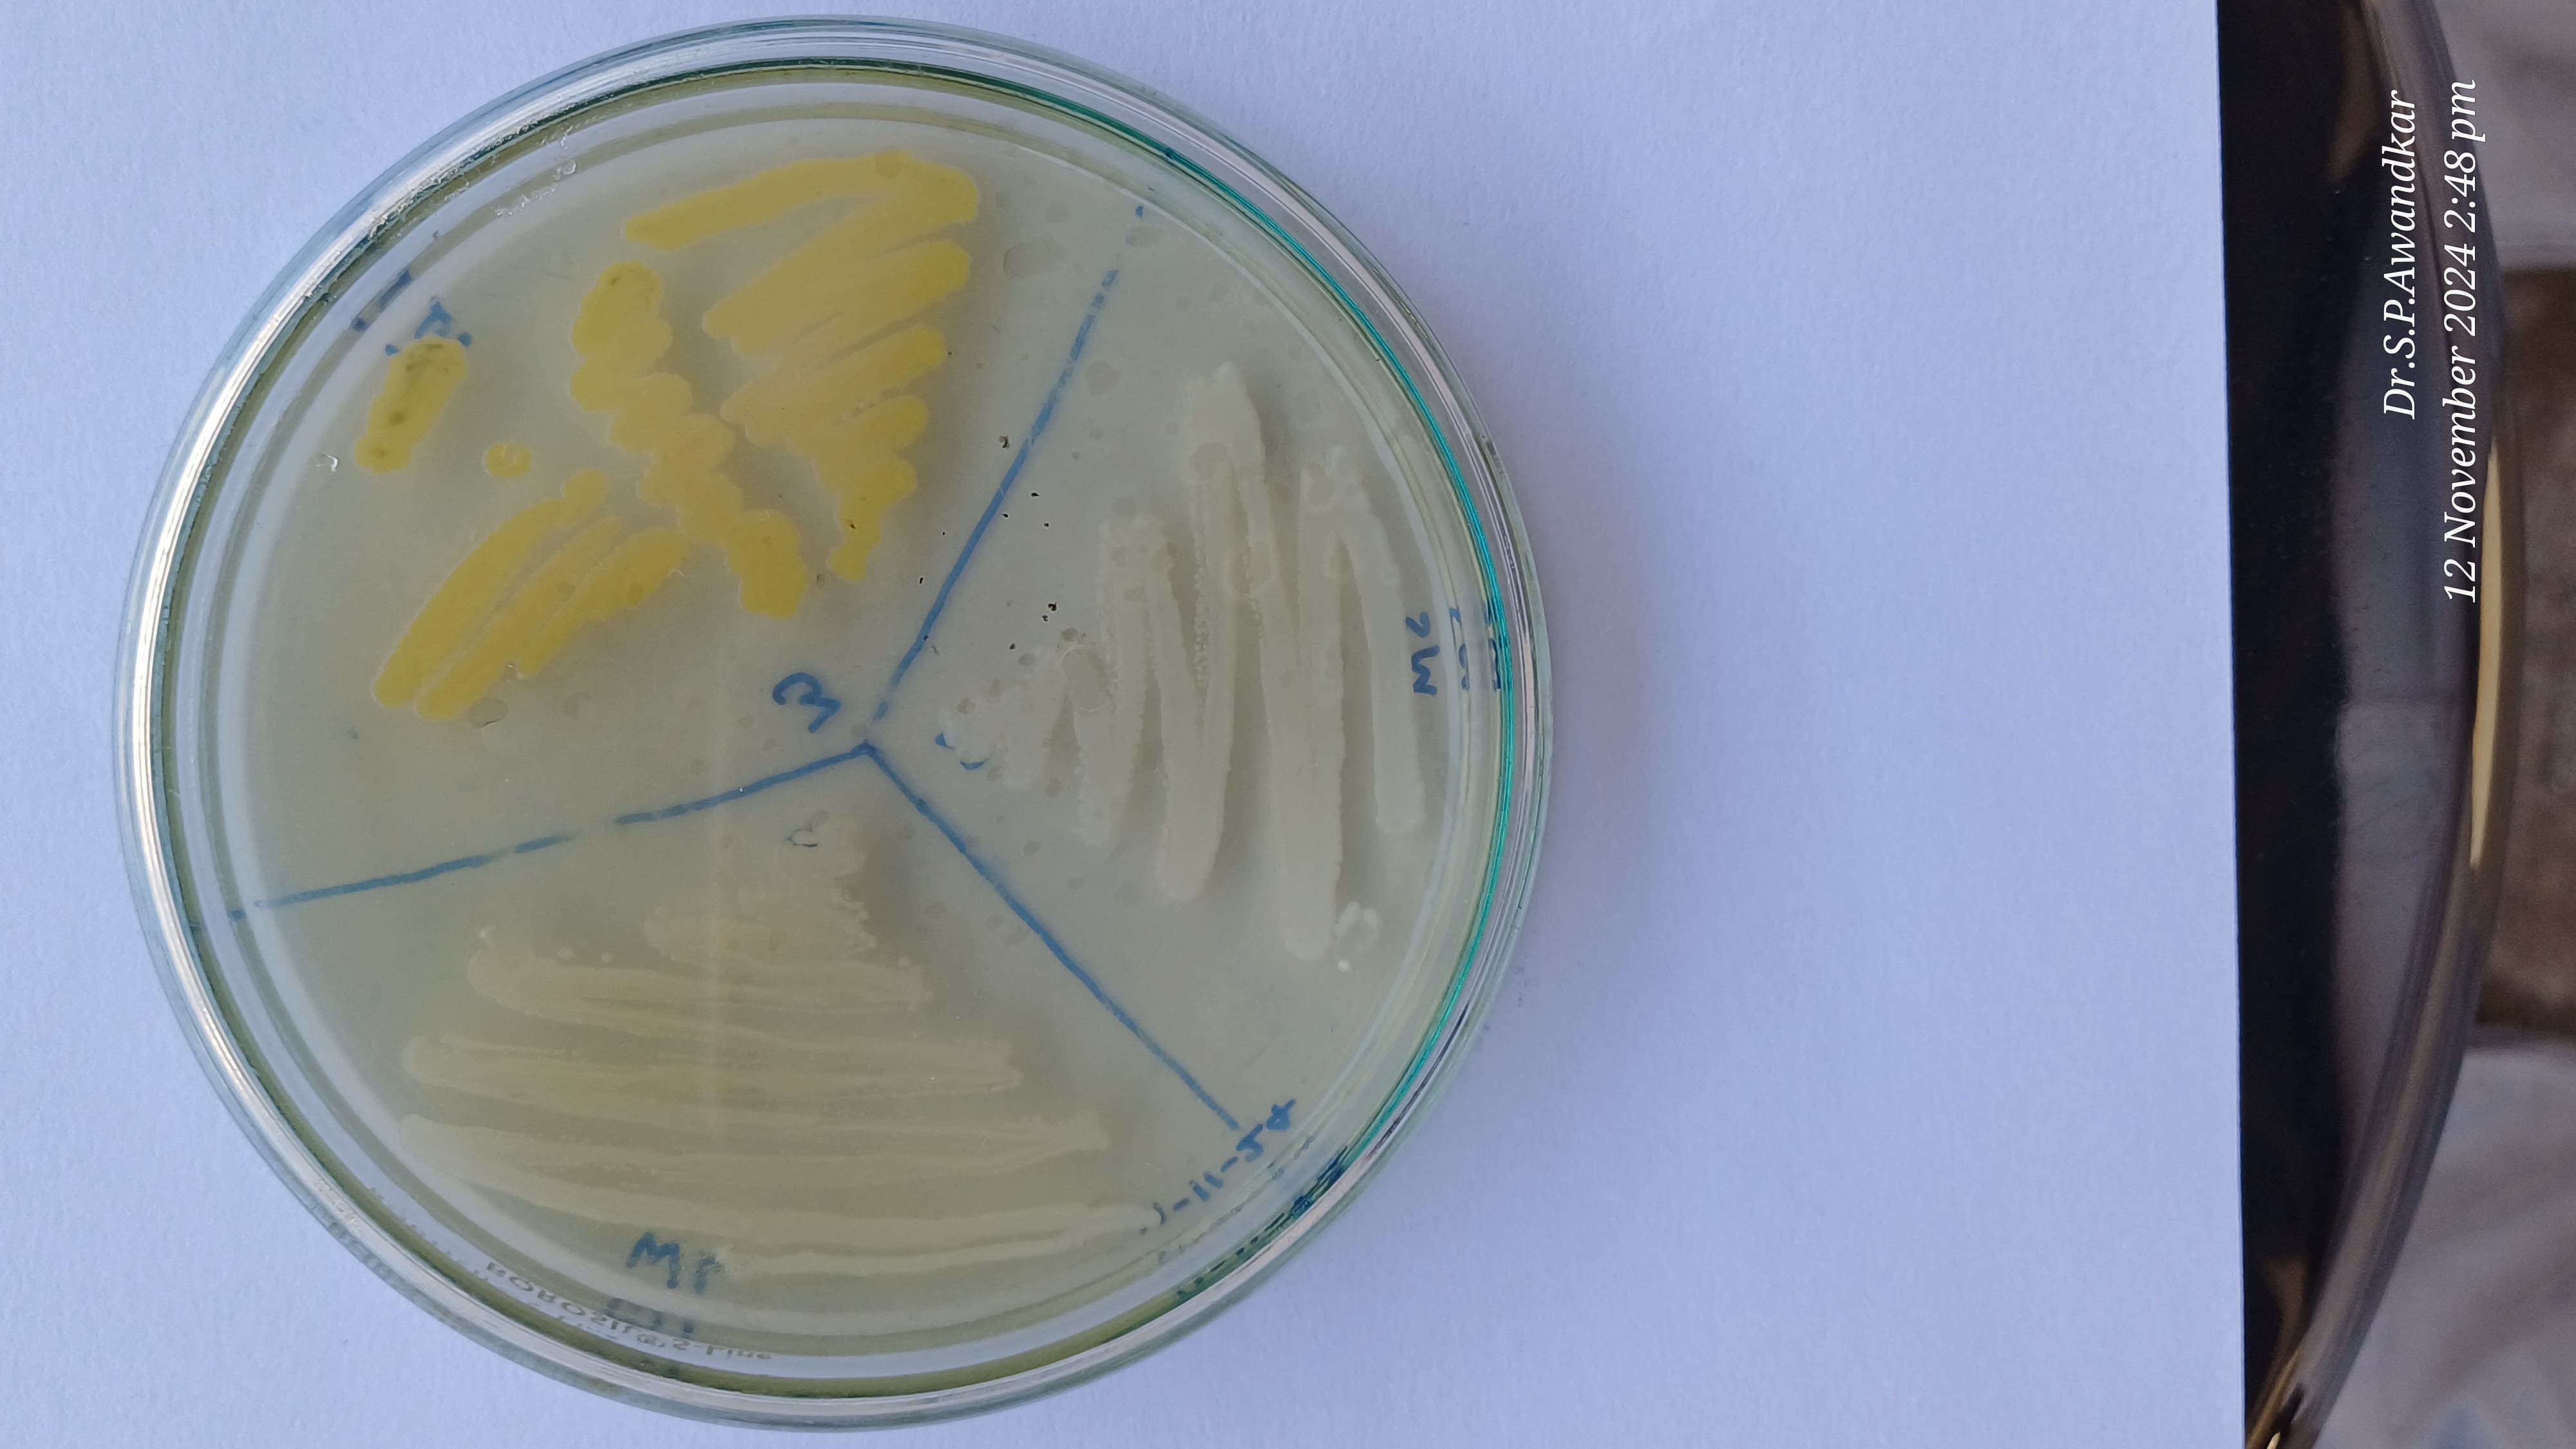
17. Staphylococci Spp
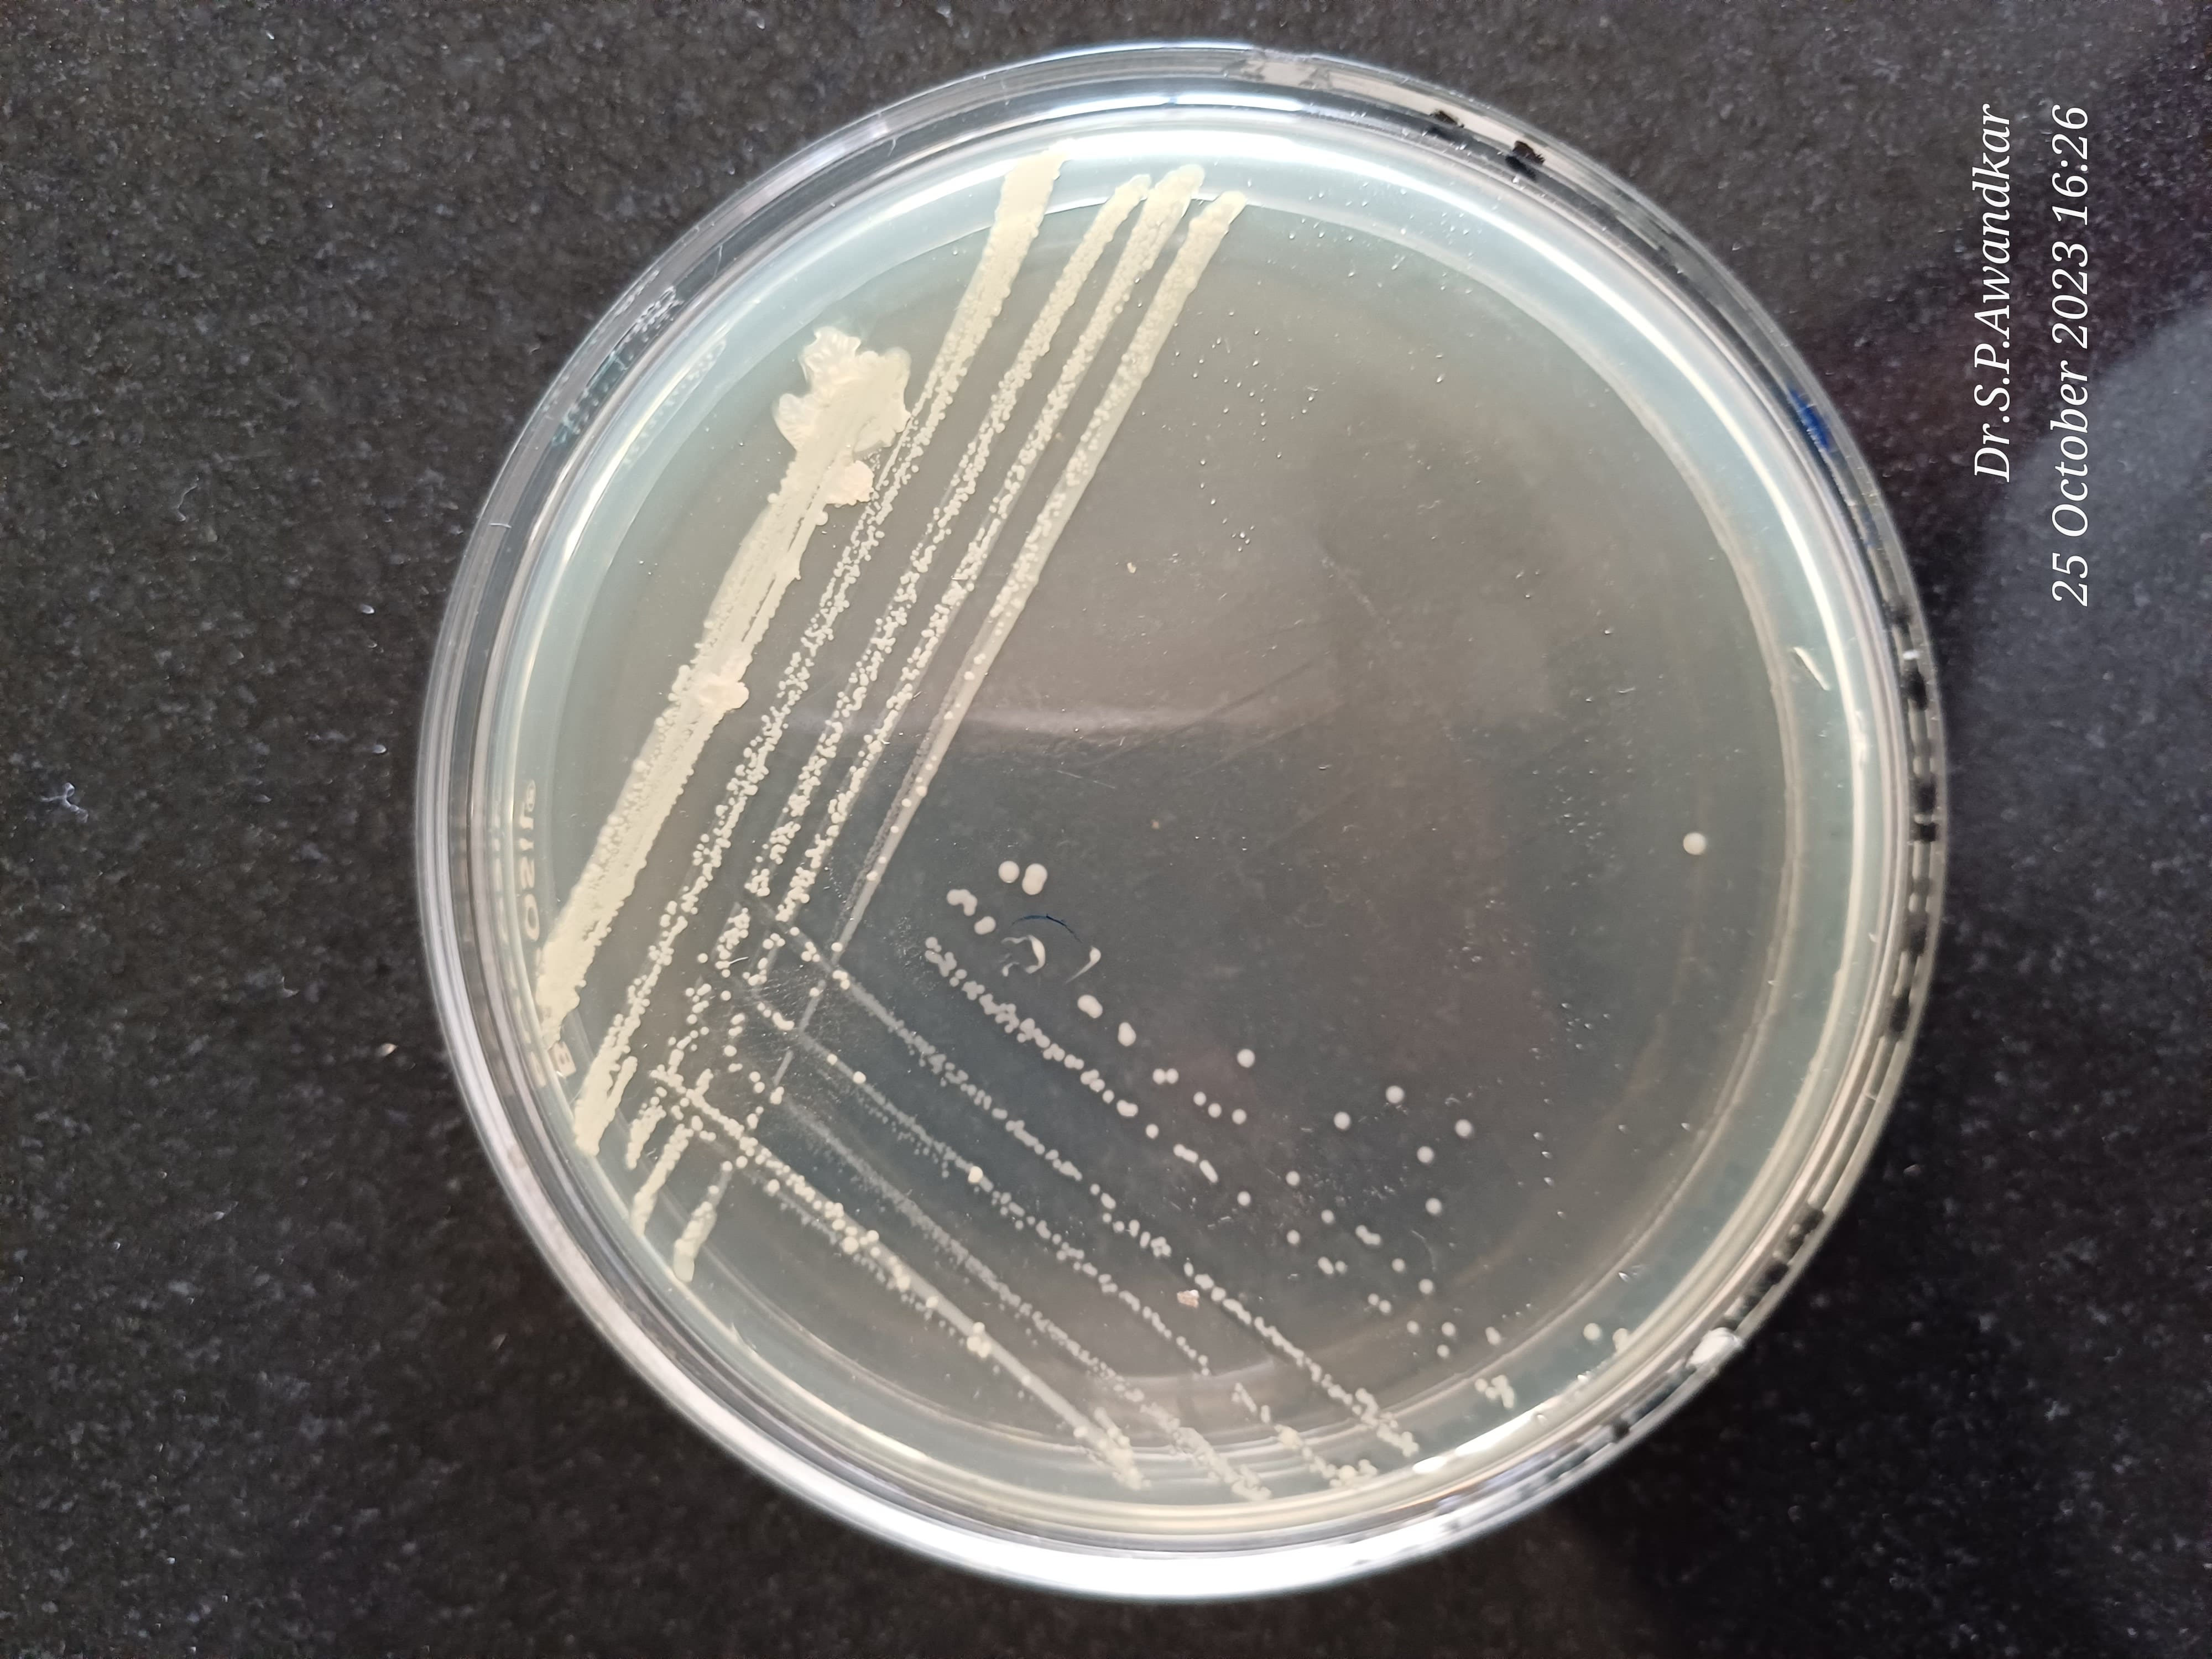
18. Bacillus Spp.
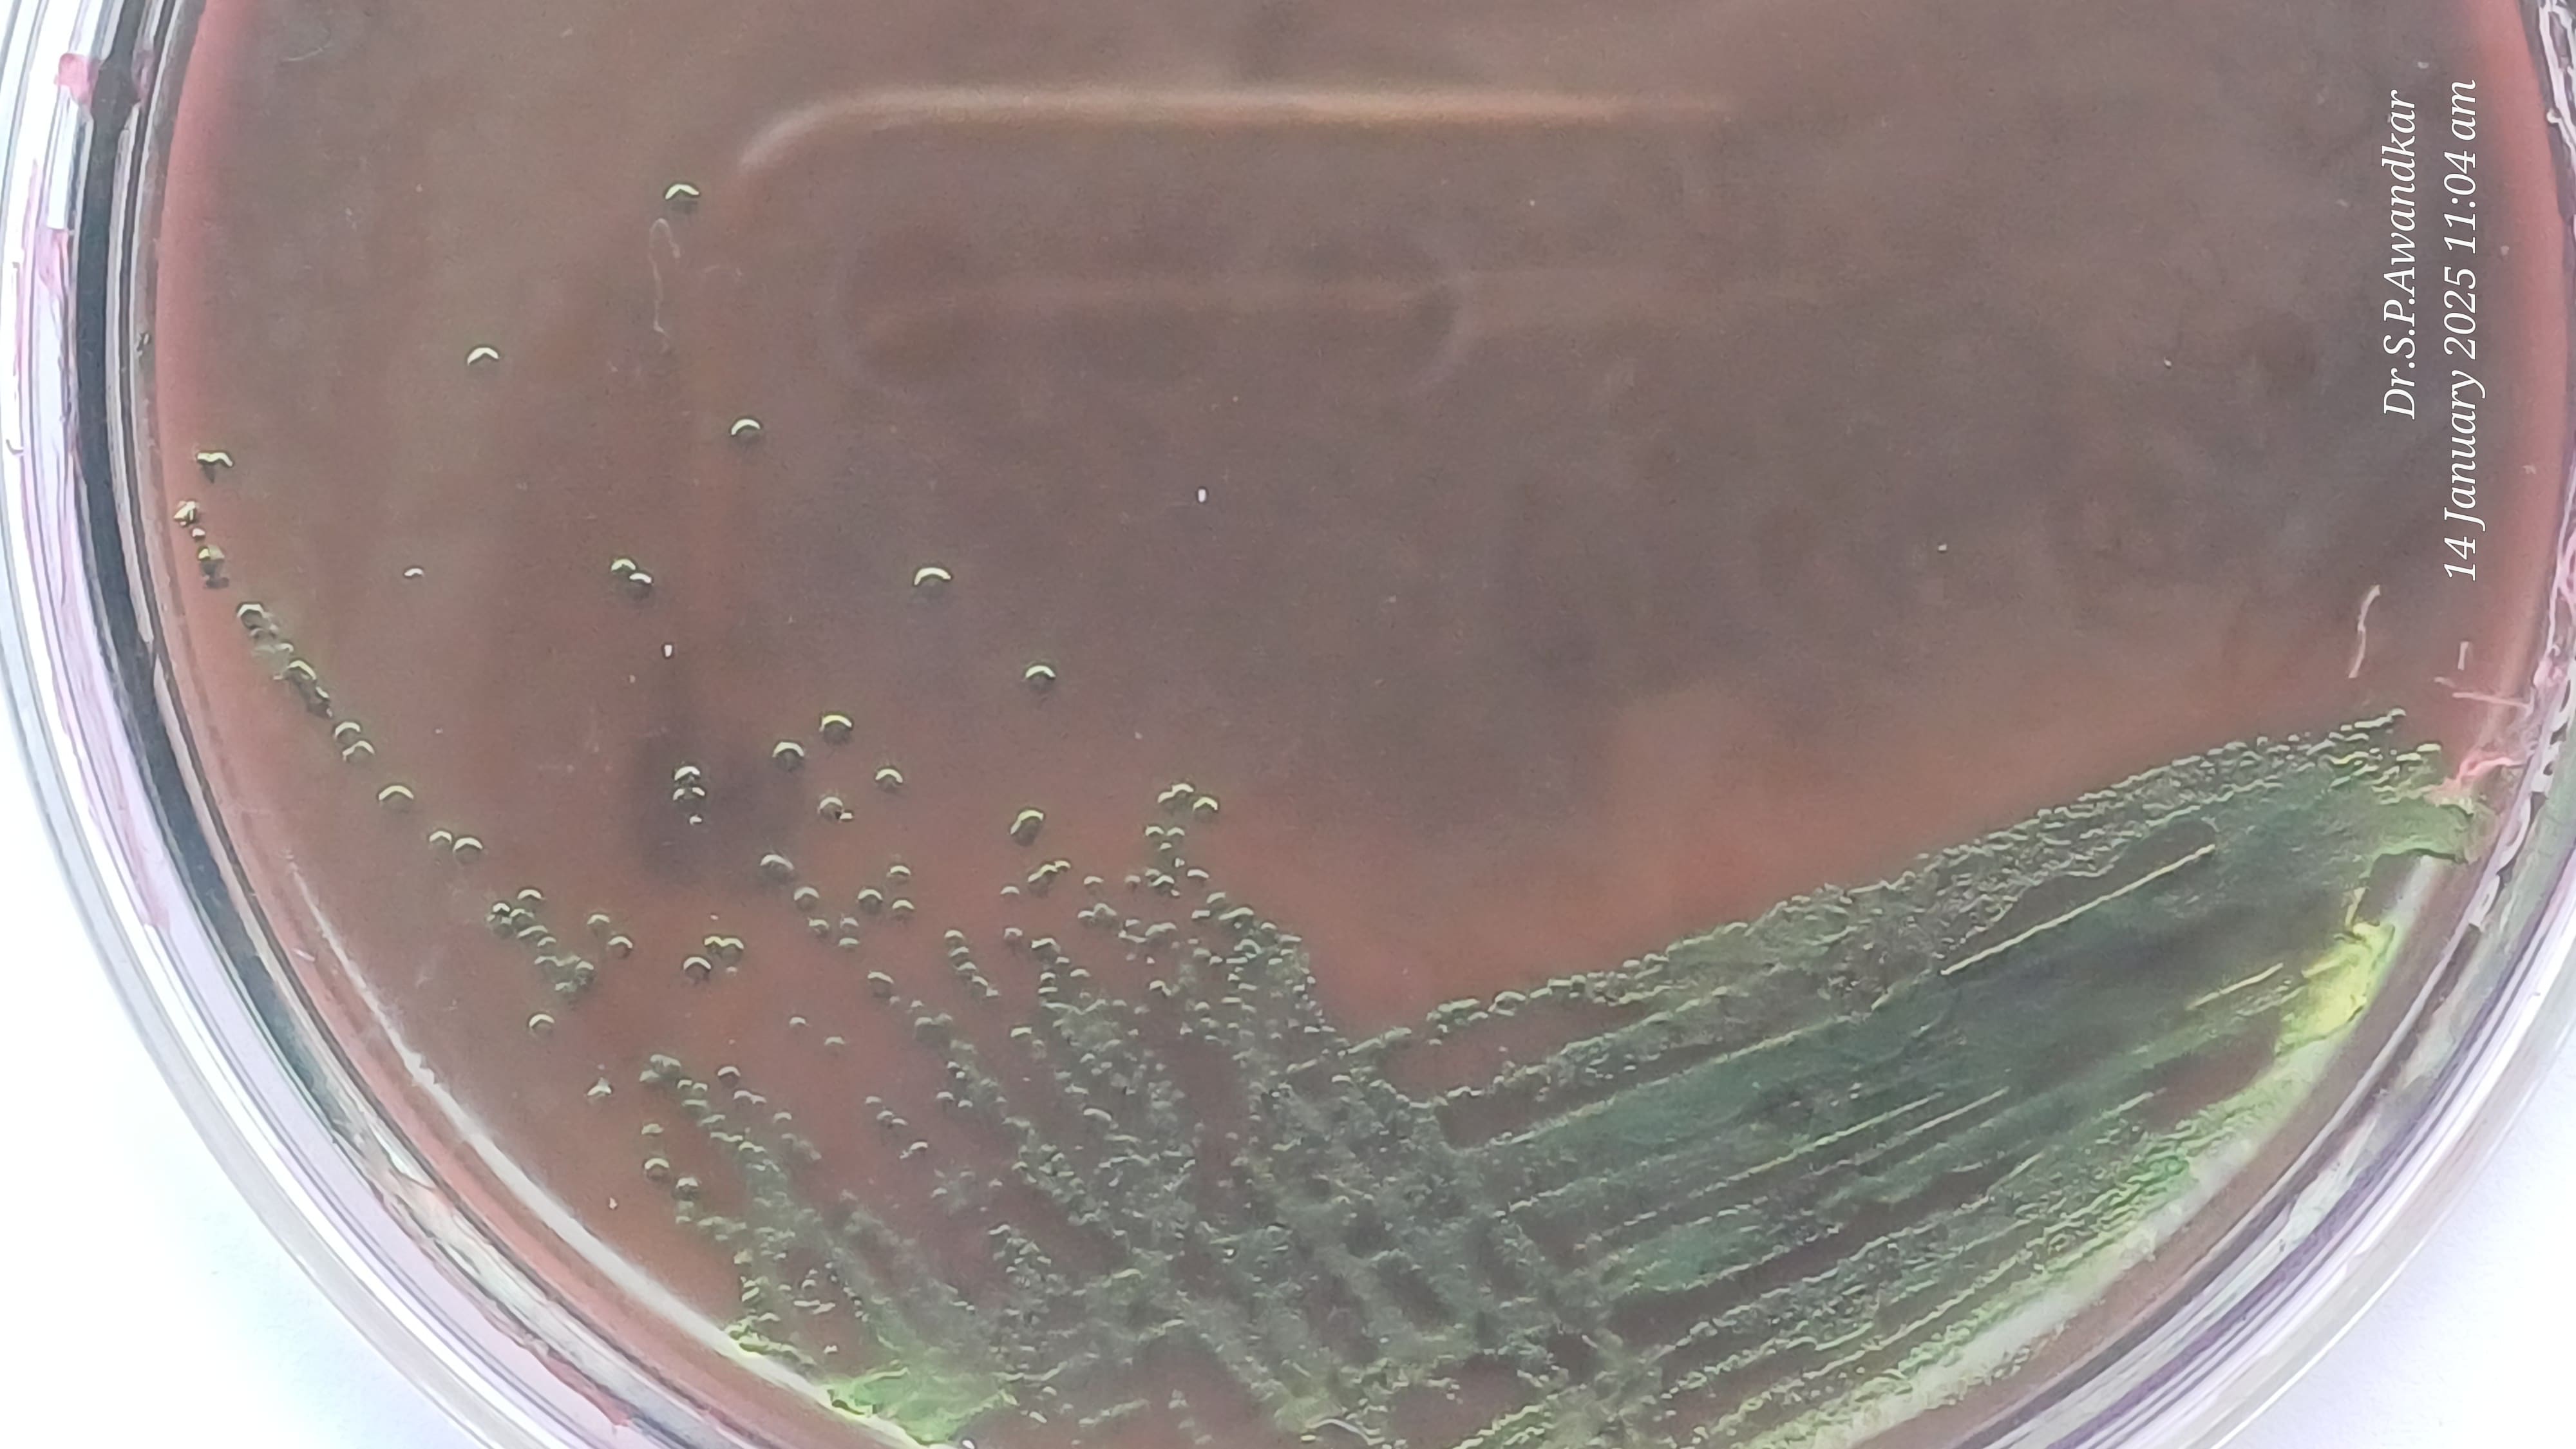
19. Avian Pathogenic E. Coli
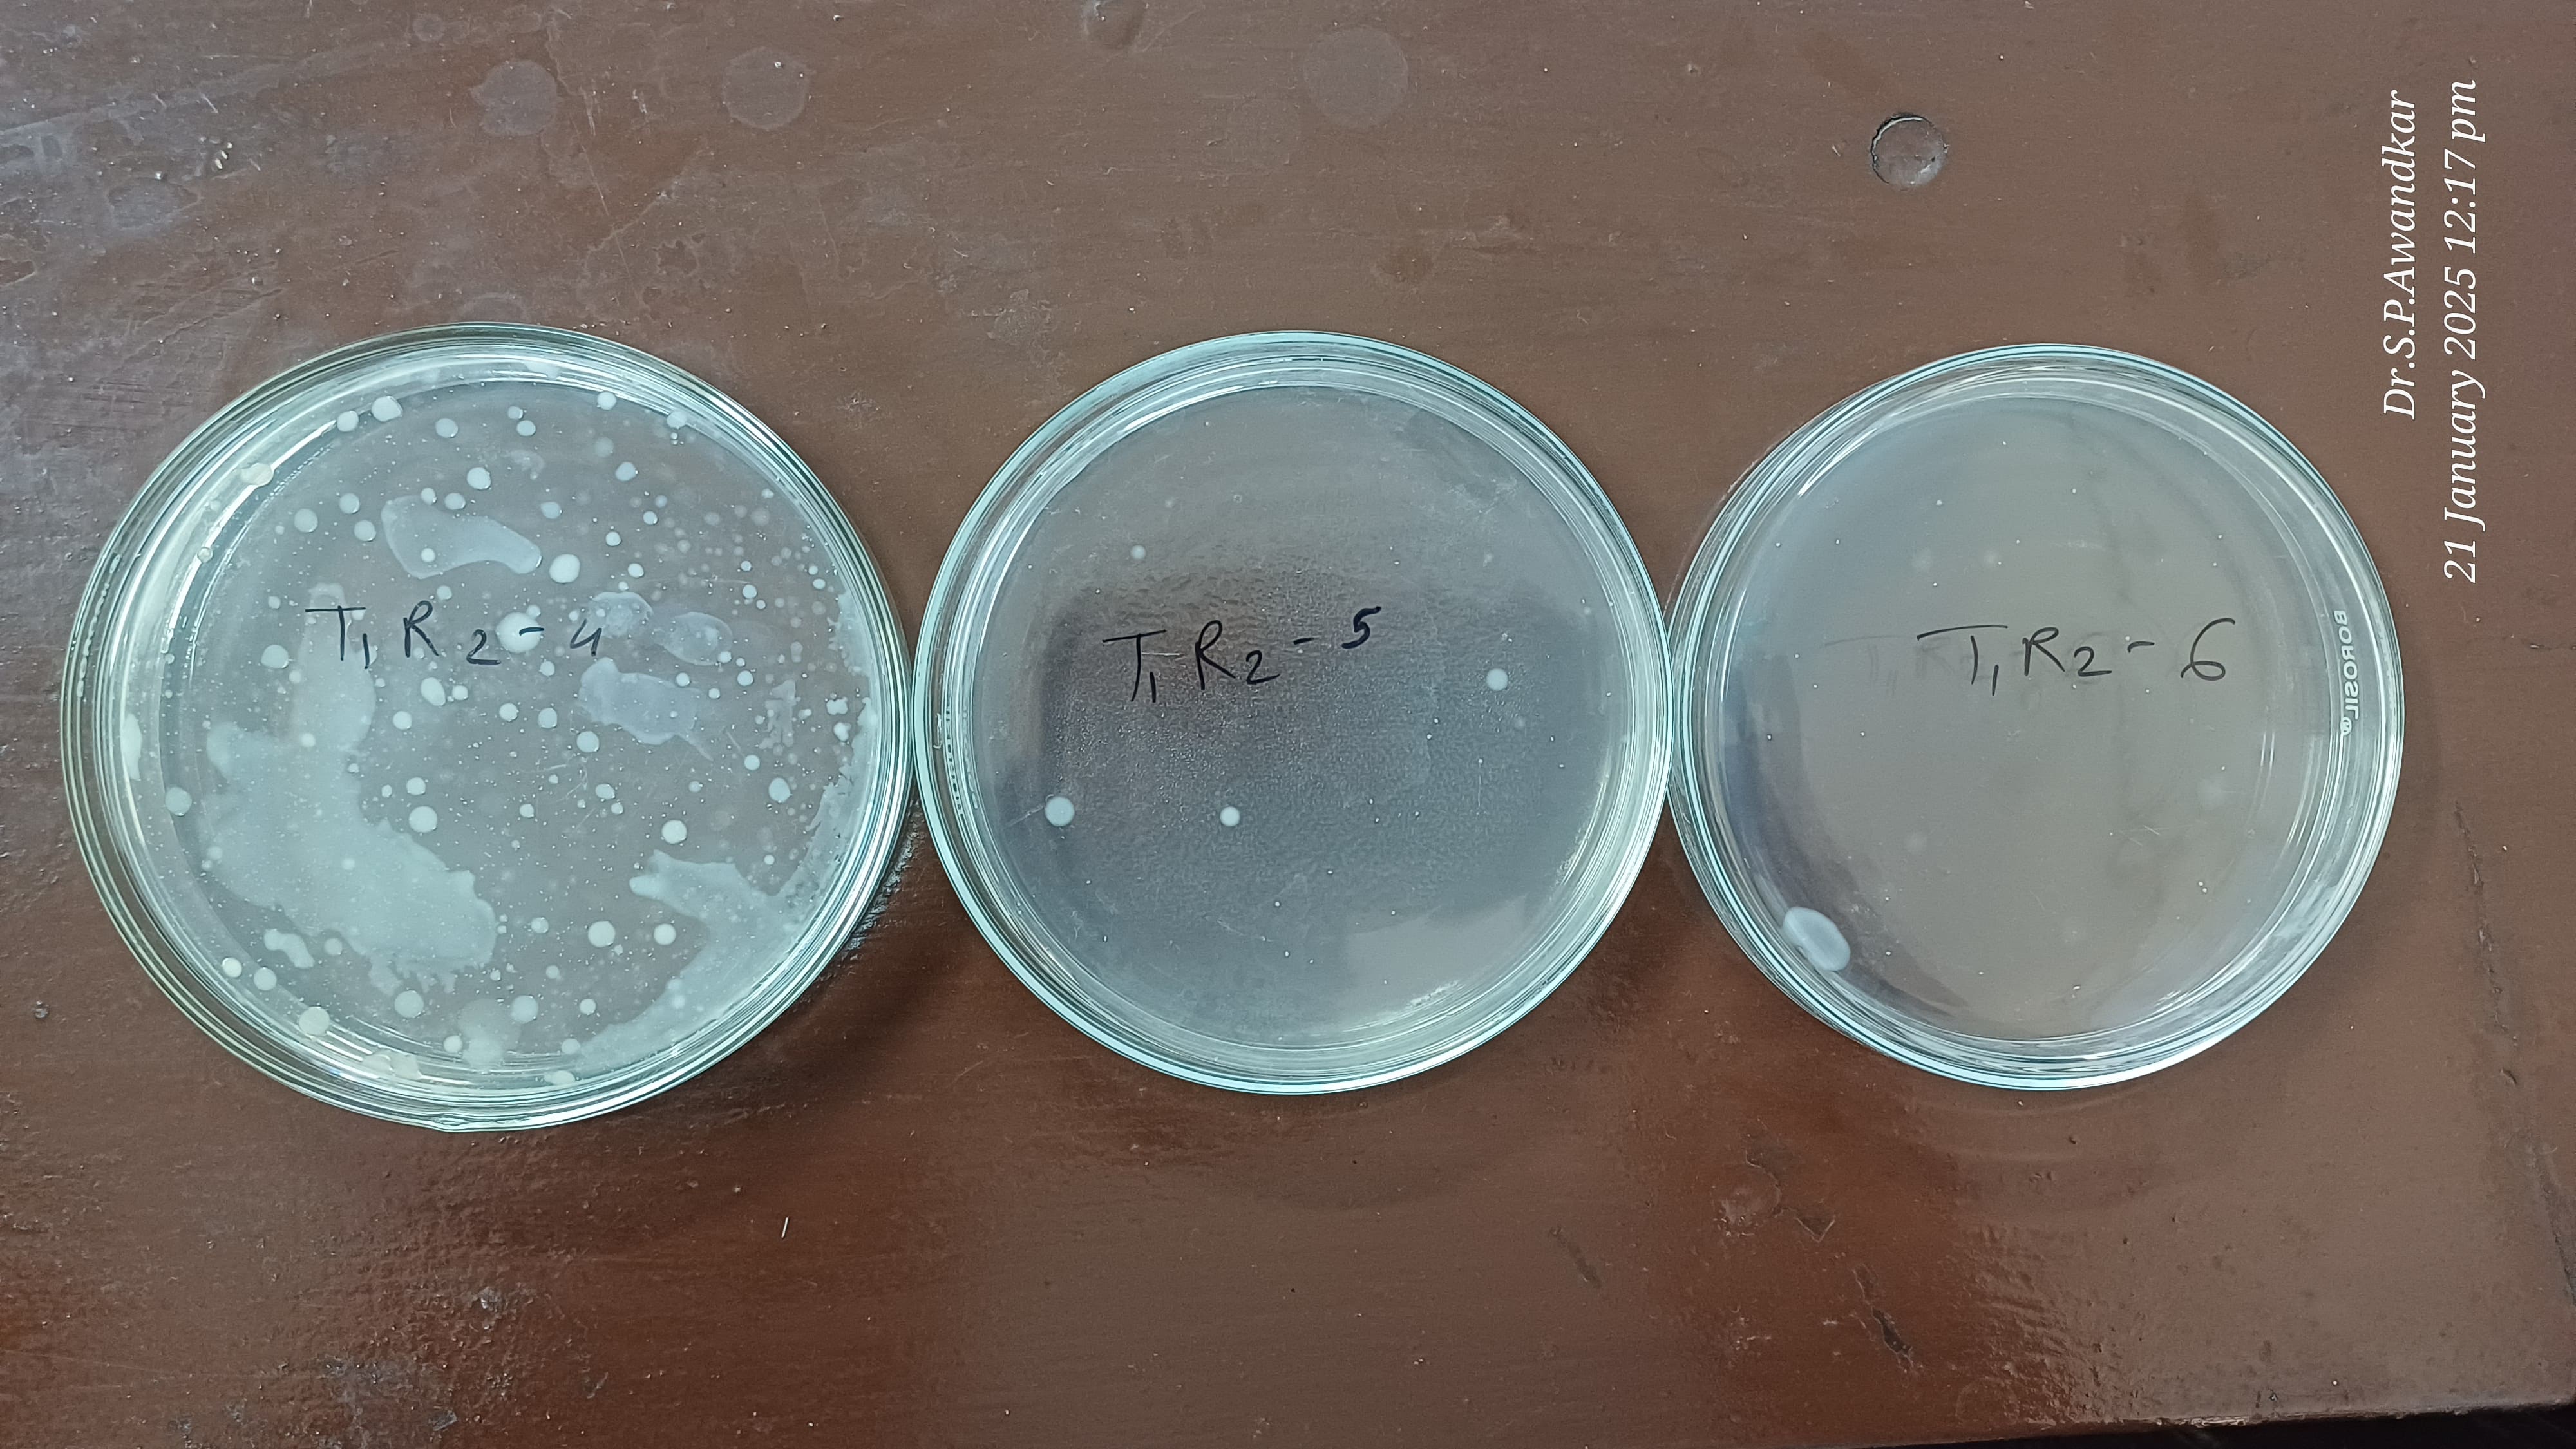
22. Total Viable Count
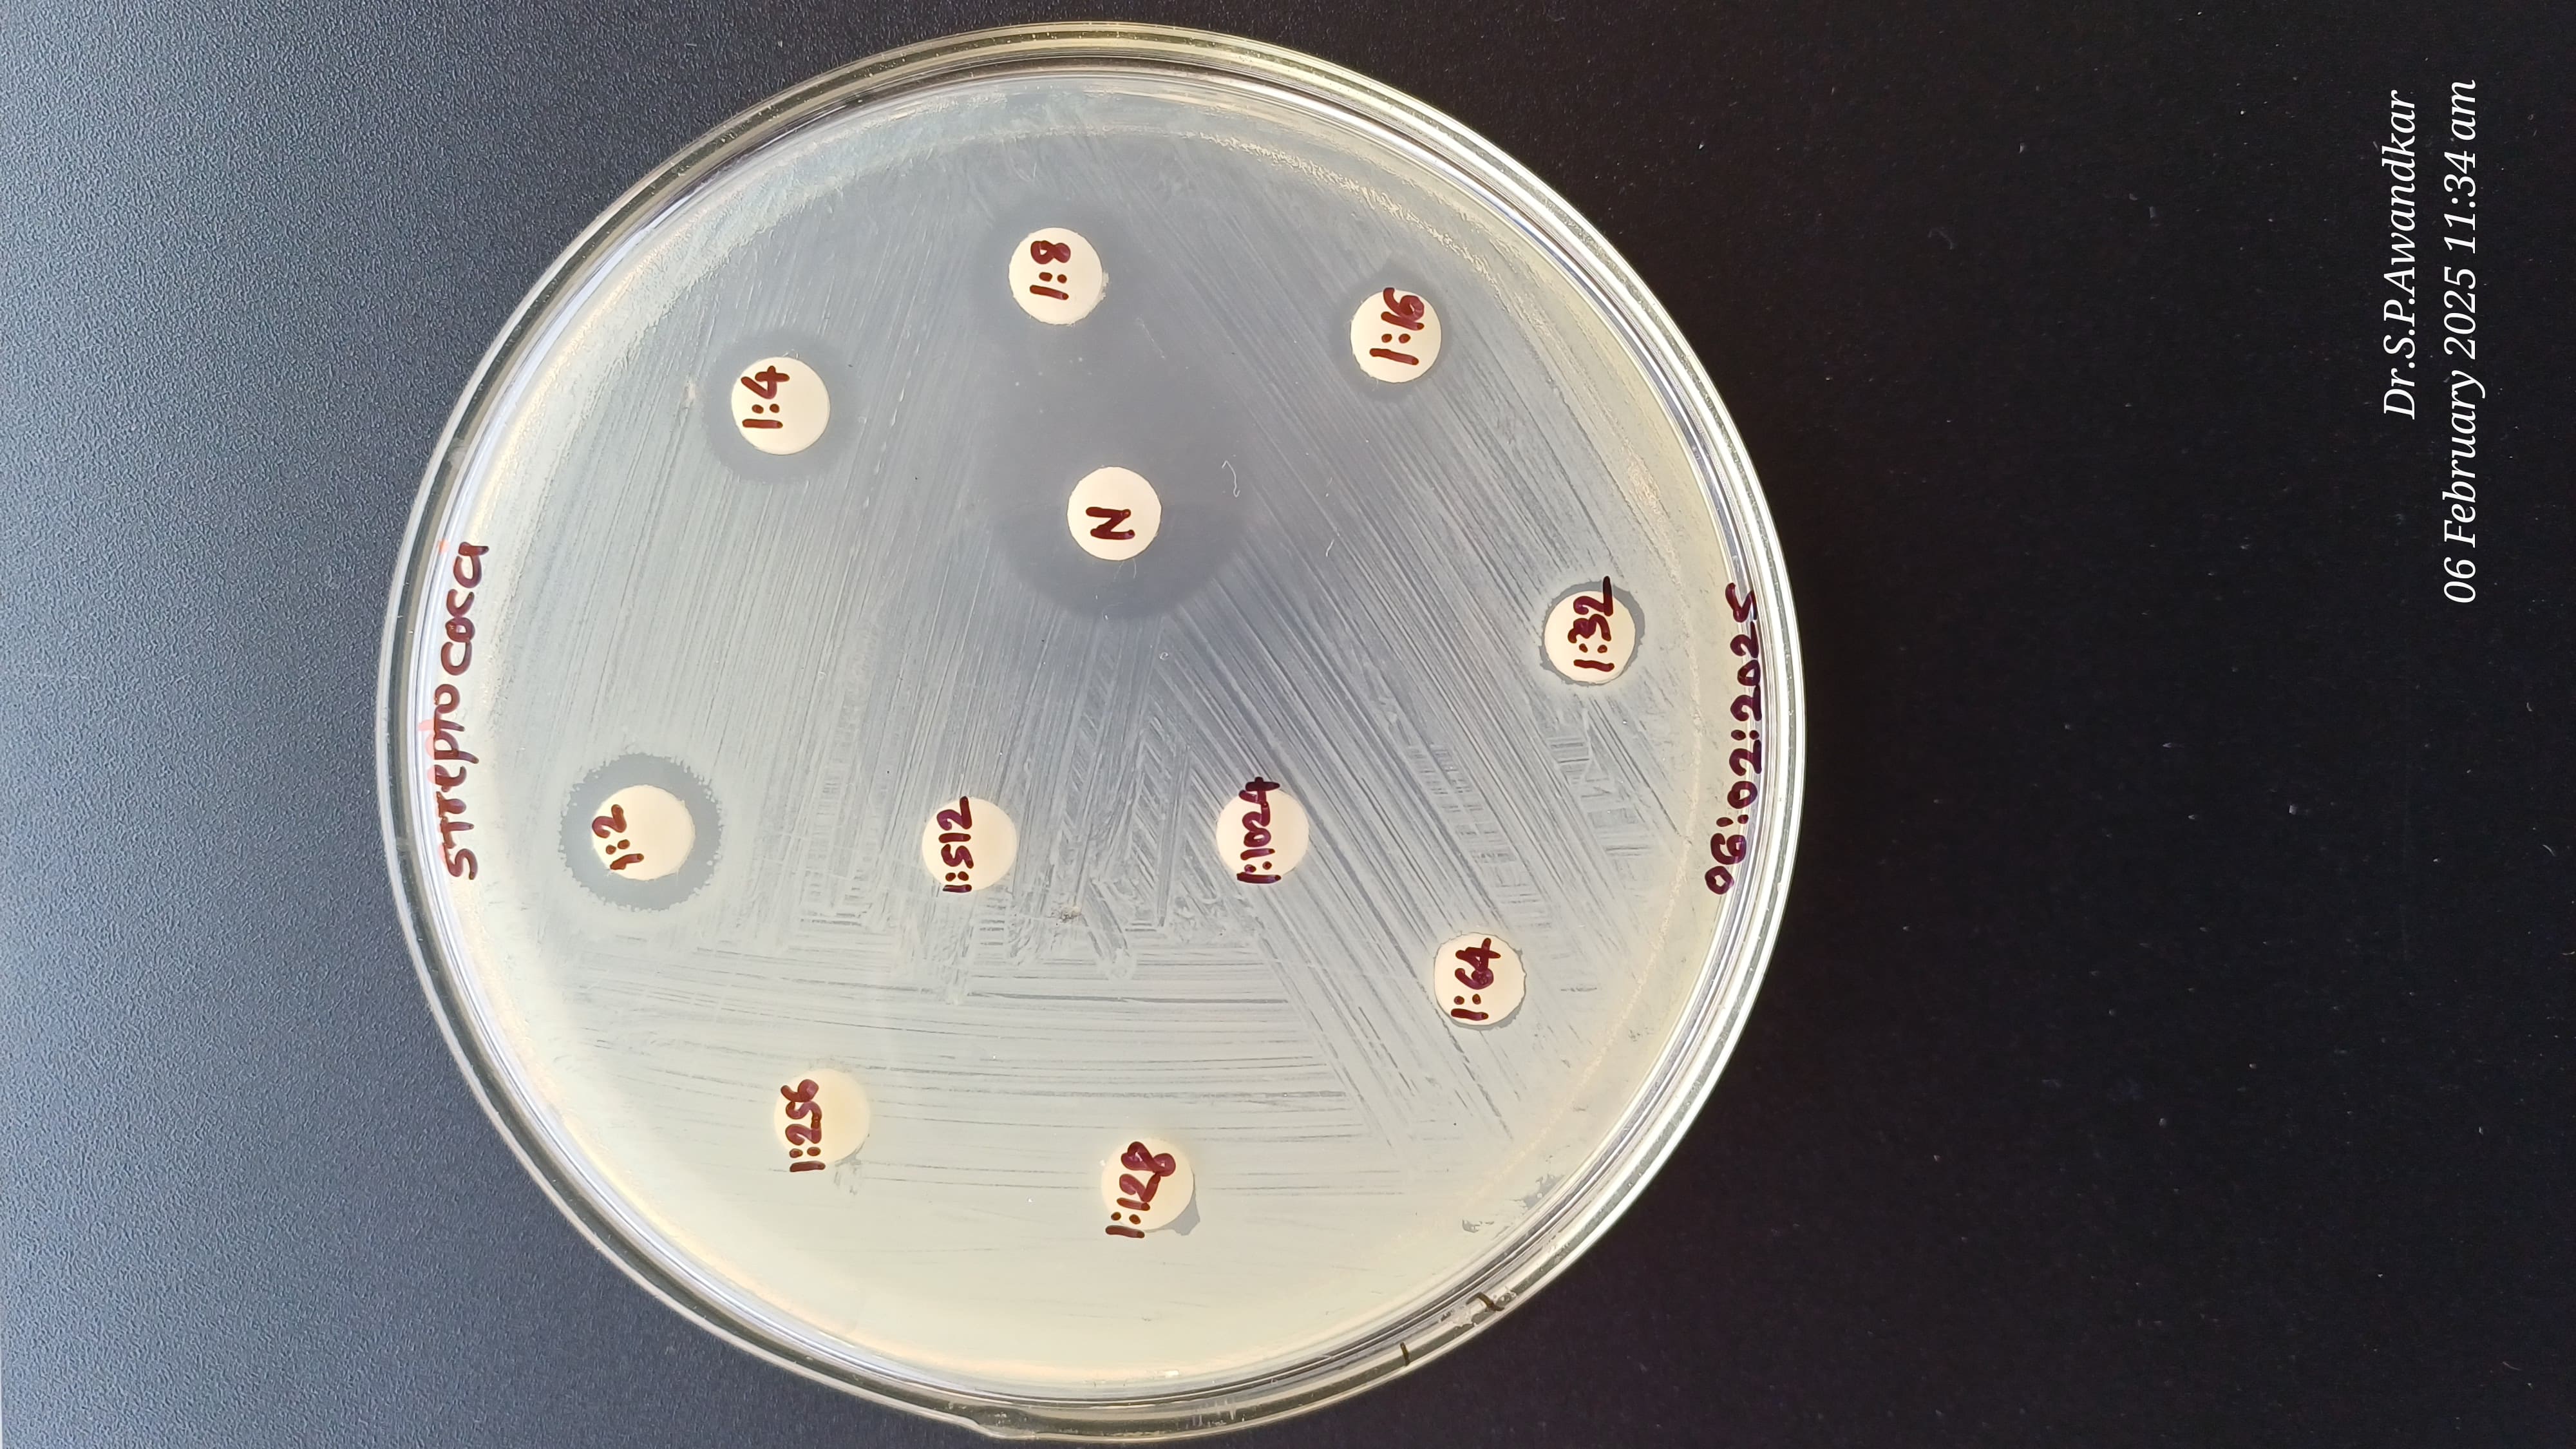
23. Antibacterial Activity Of Herbal Teat Dip
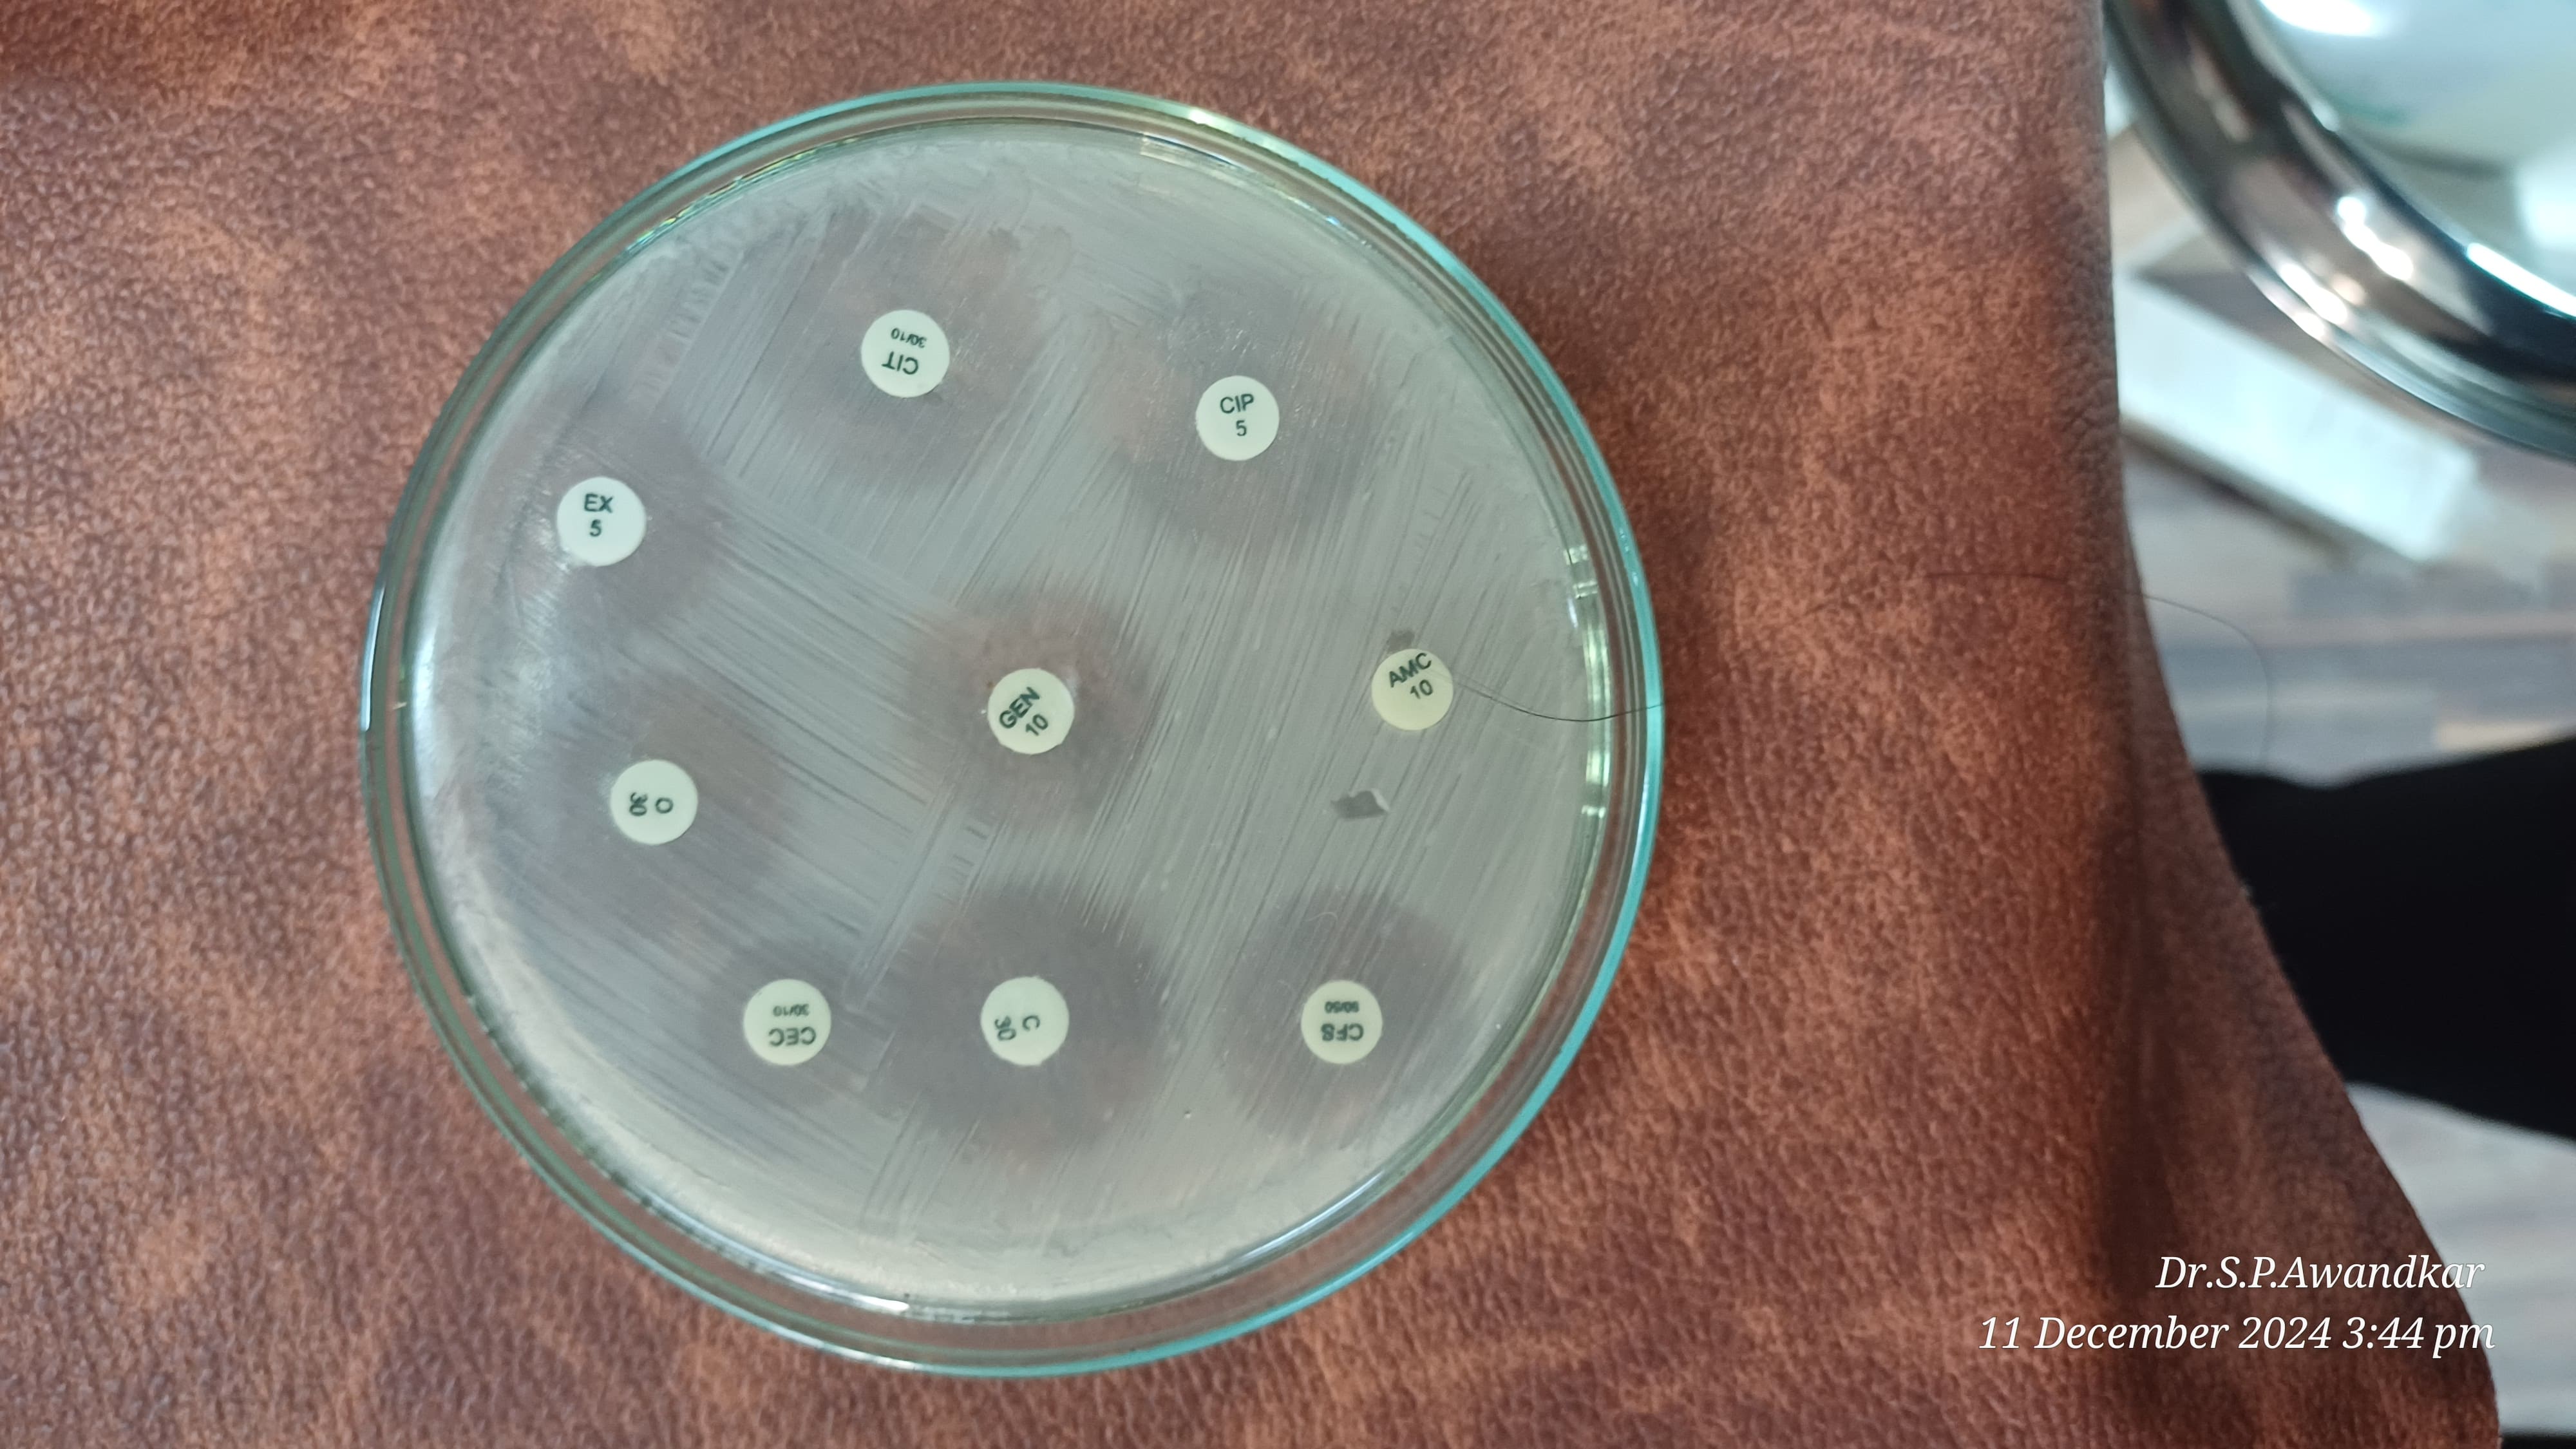
24. Antibiotic Sensitivity Test
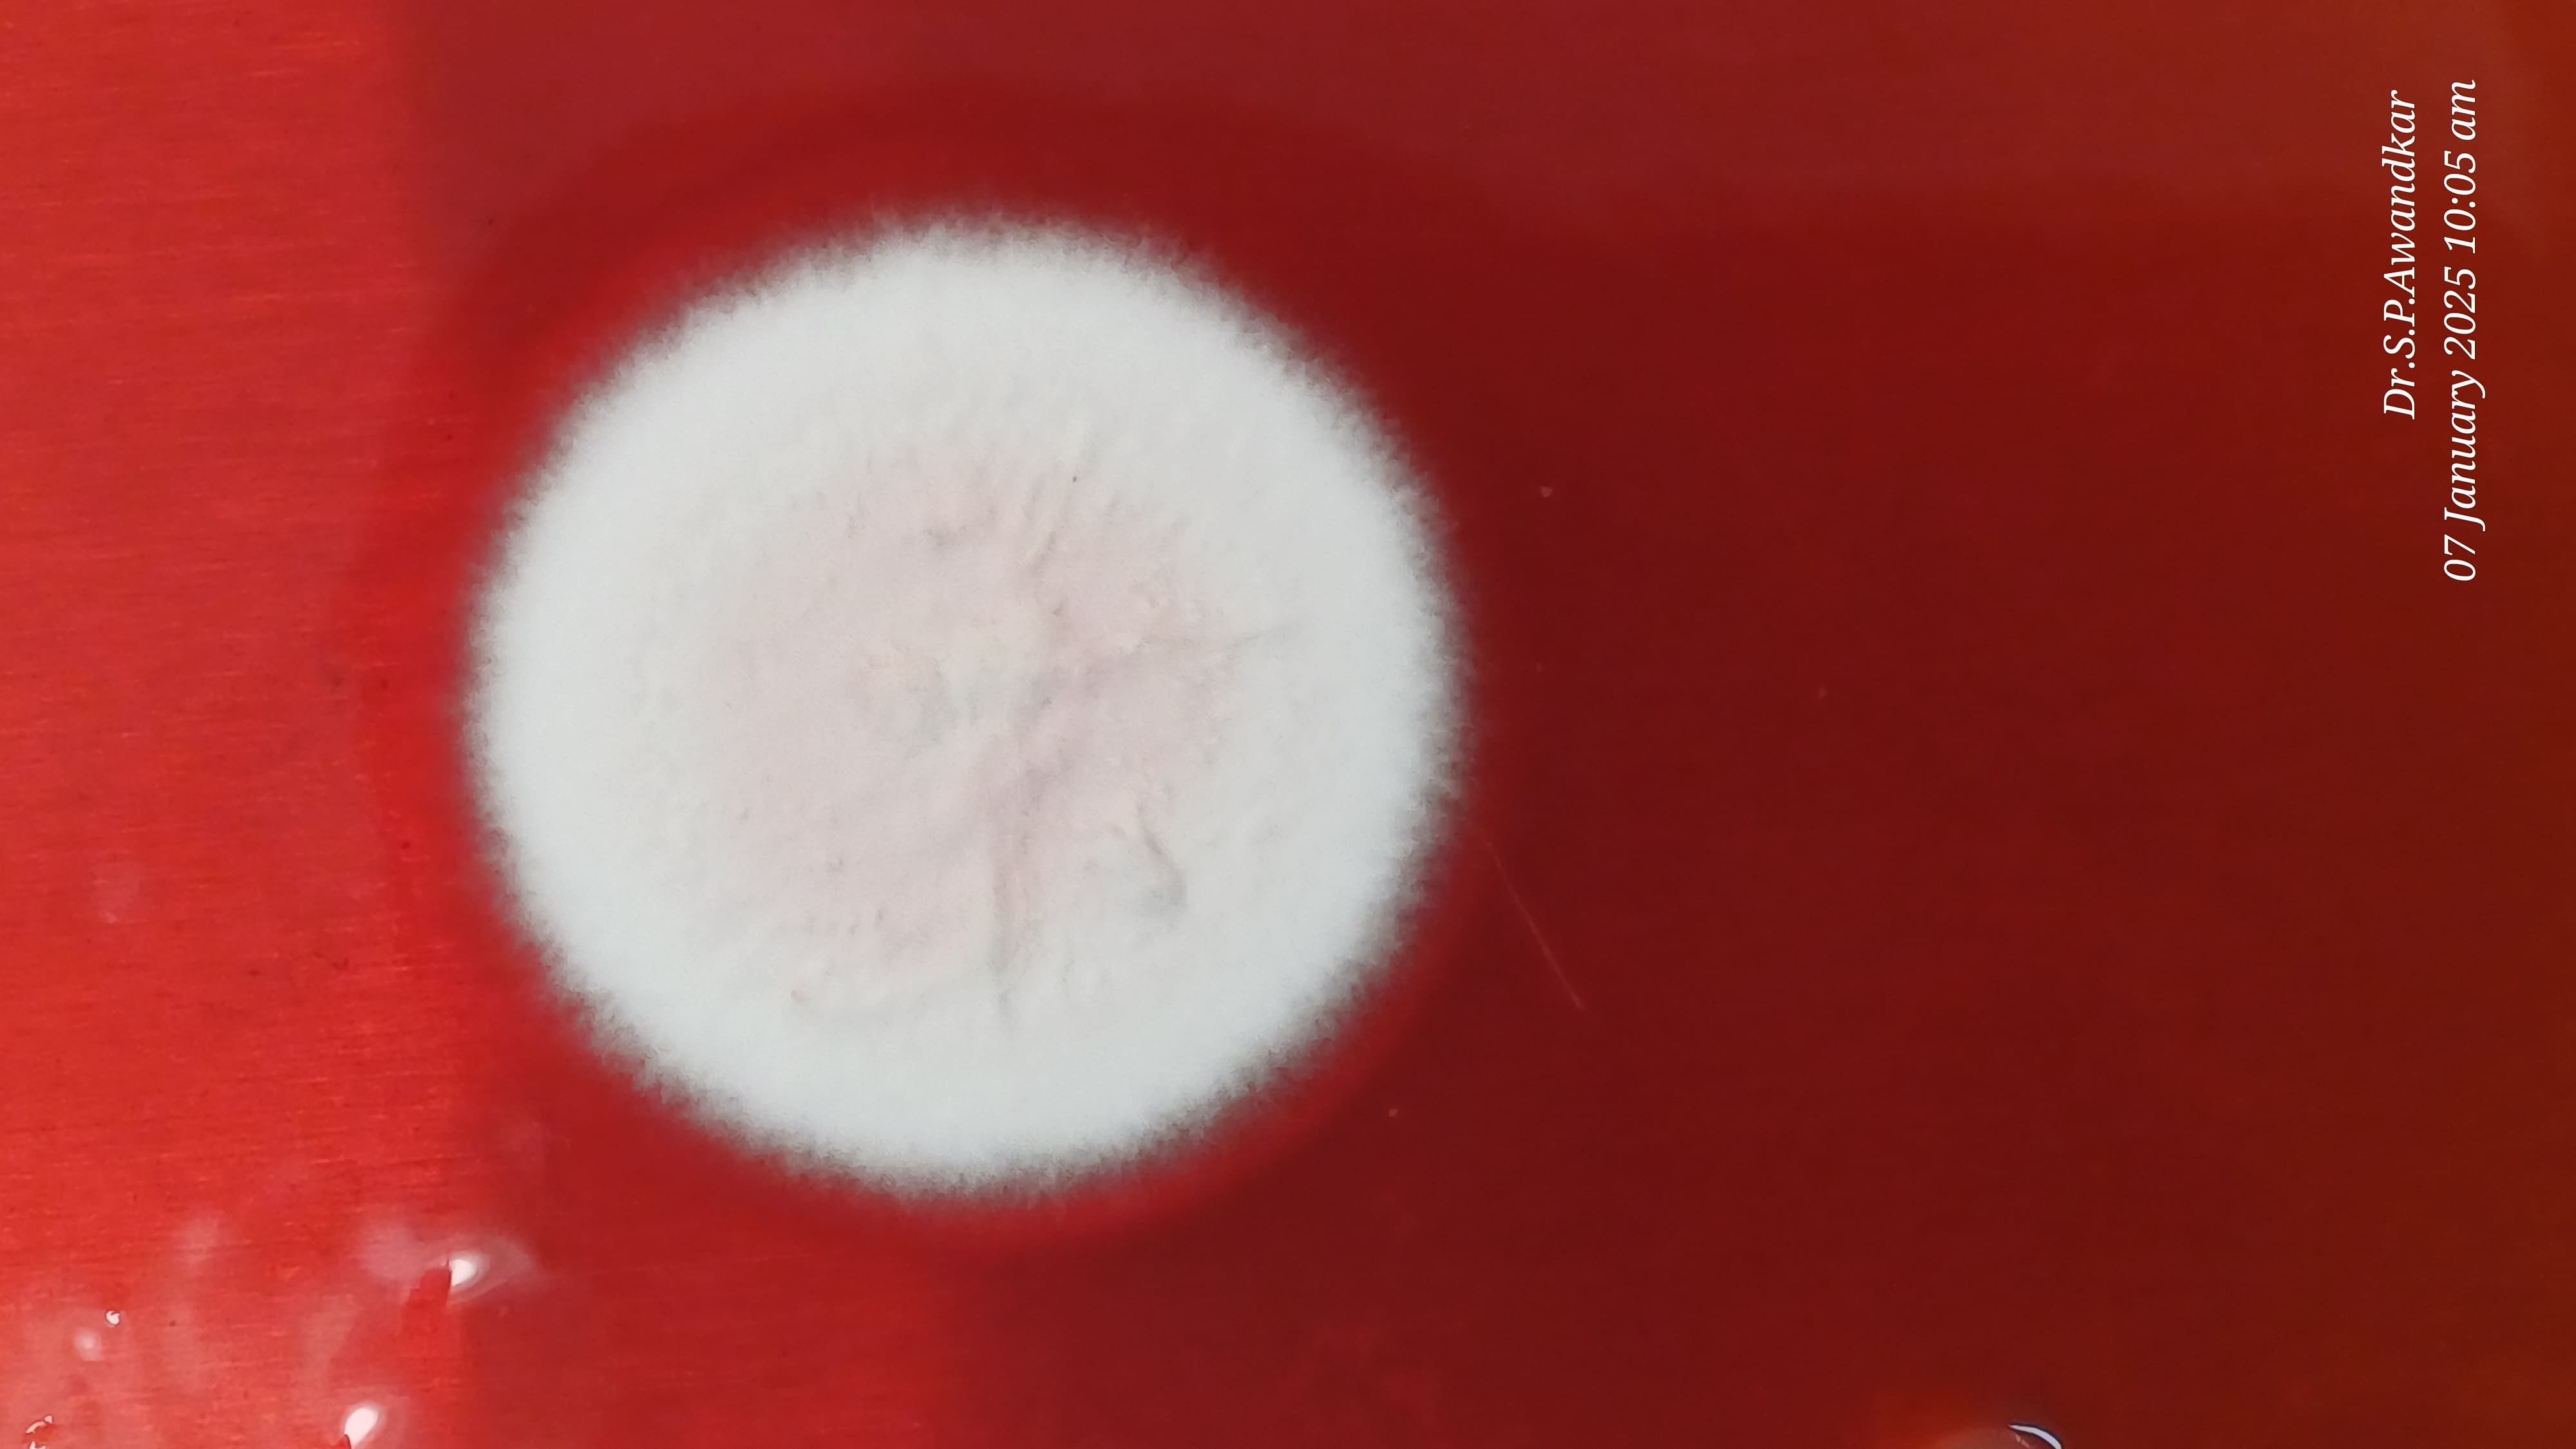
30. Trichophyton Mentagrophytes
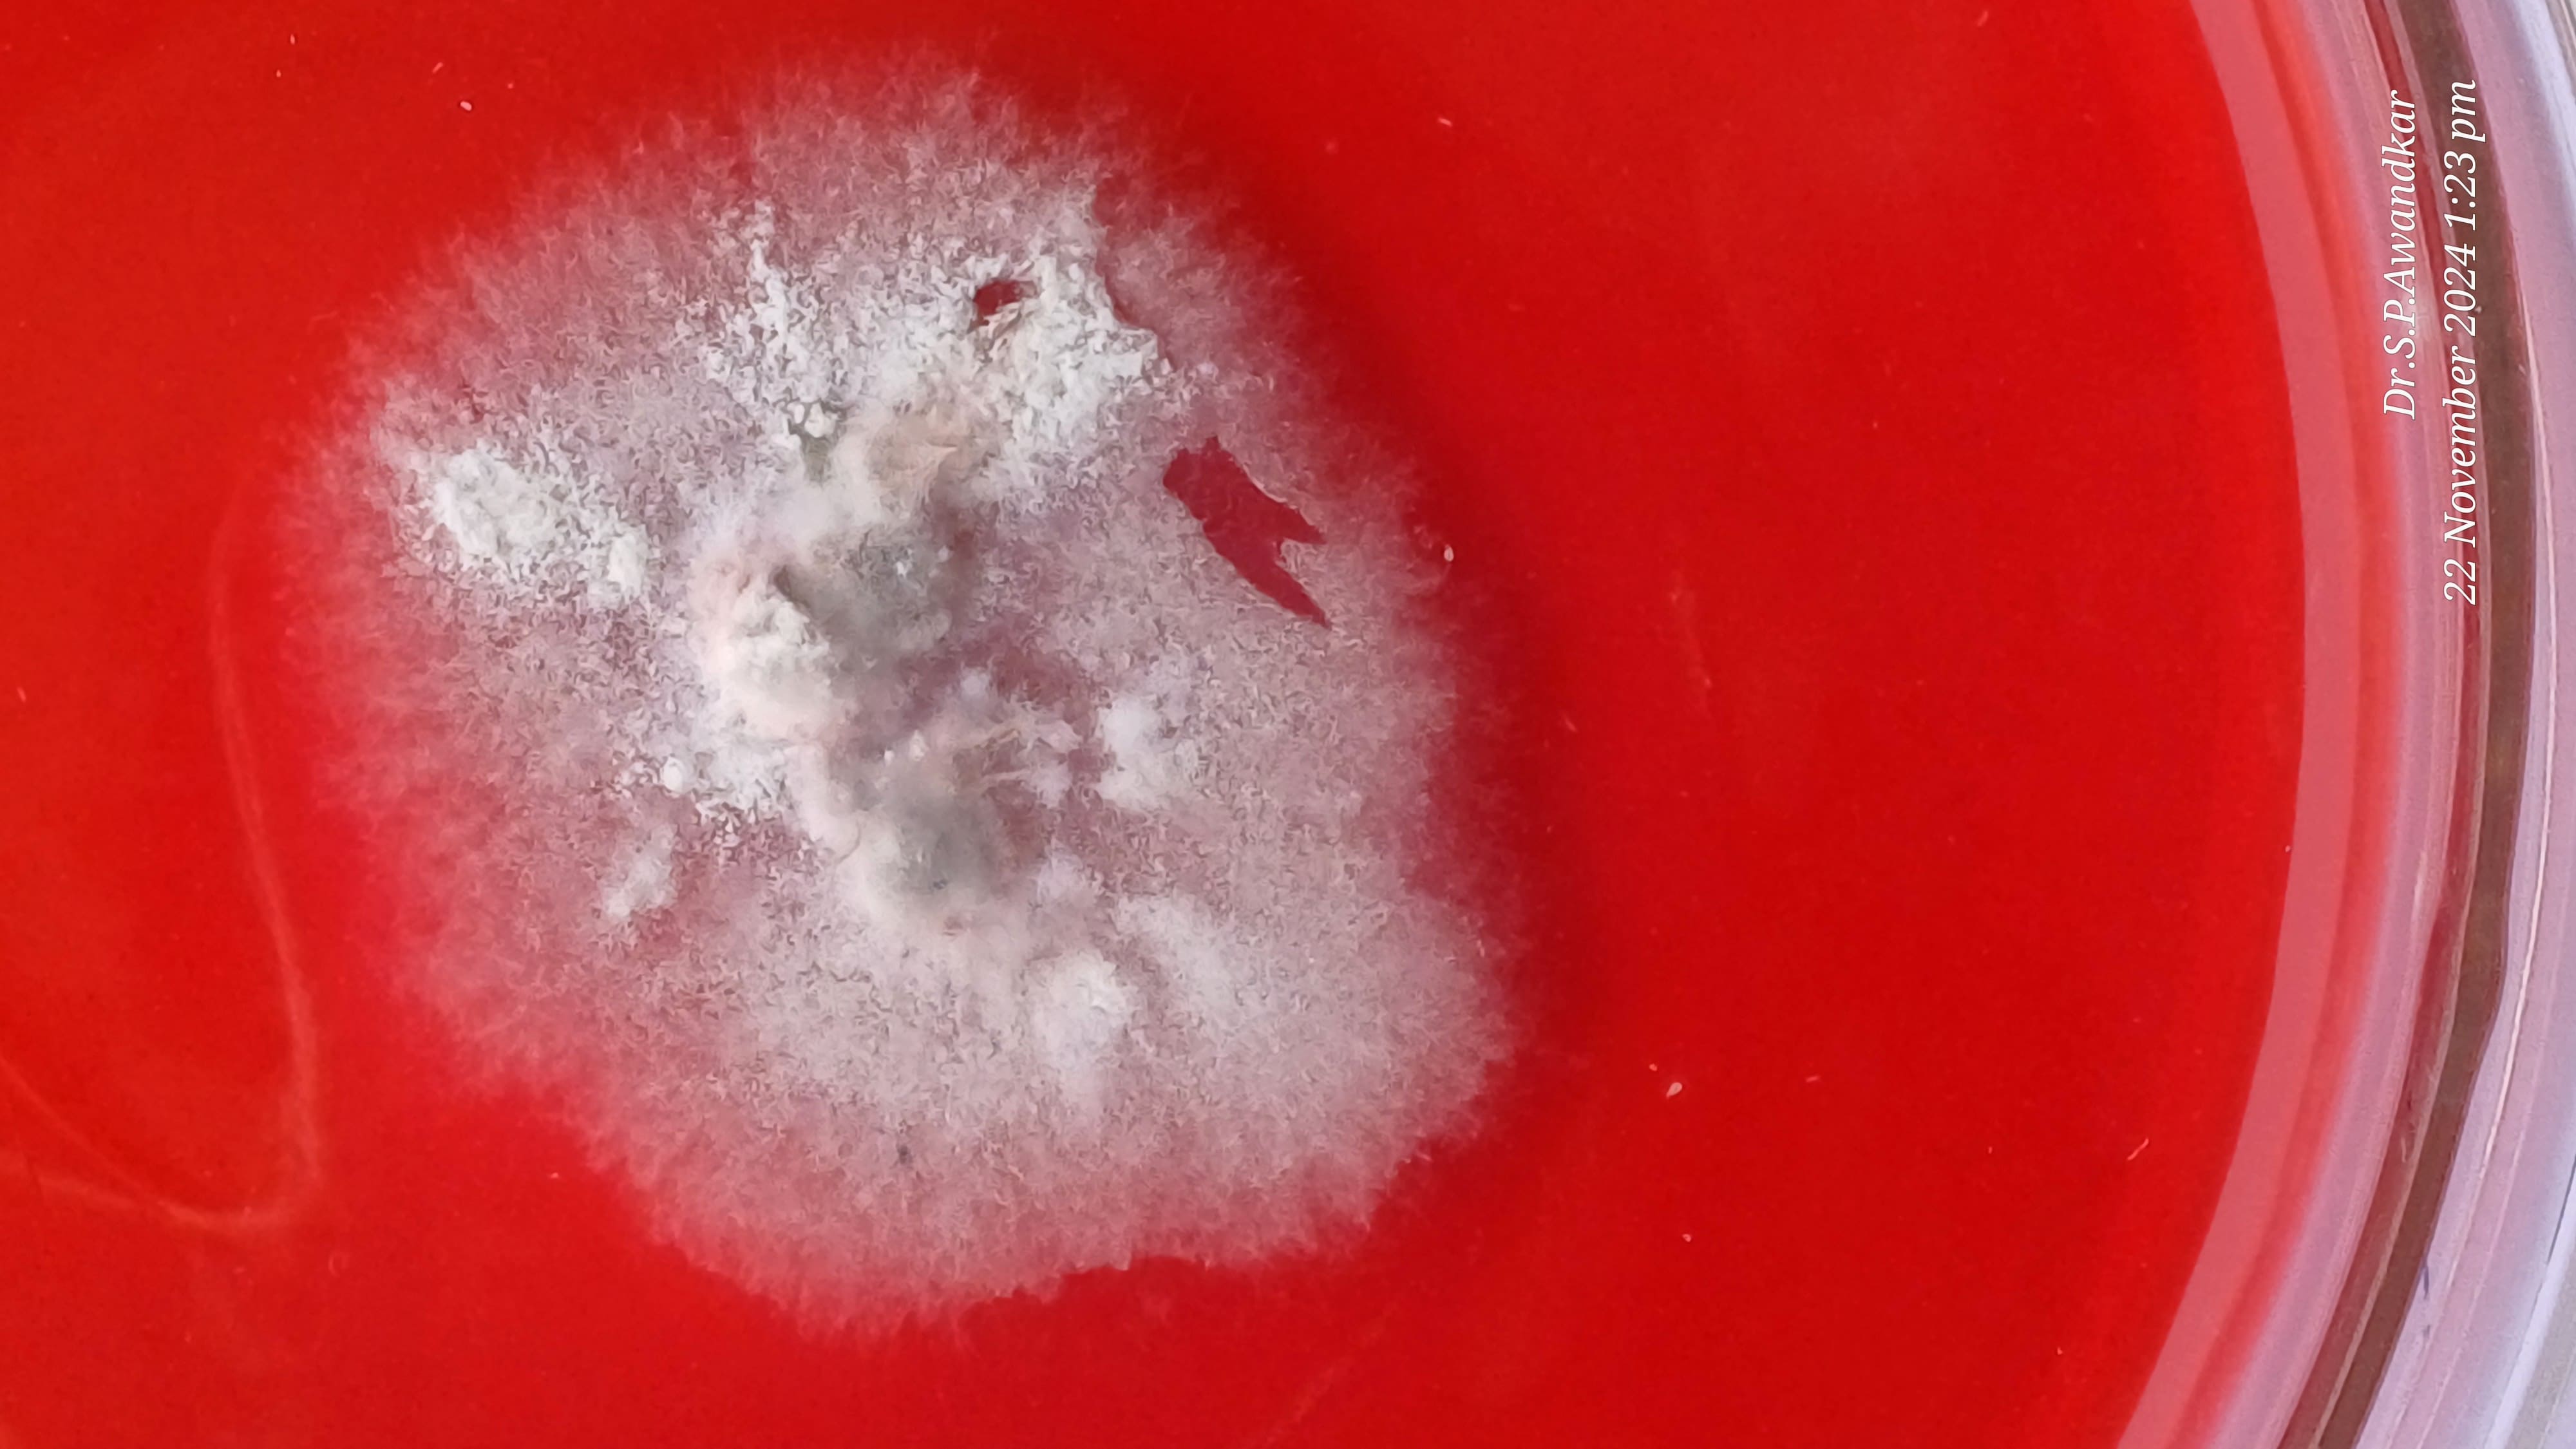
32. Trichophyton Mentagrophytes
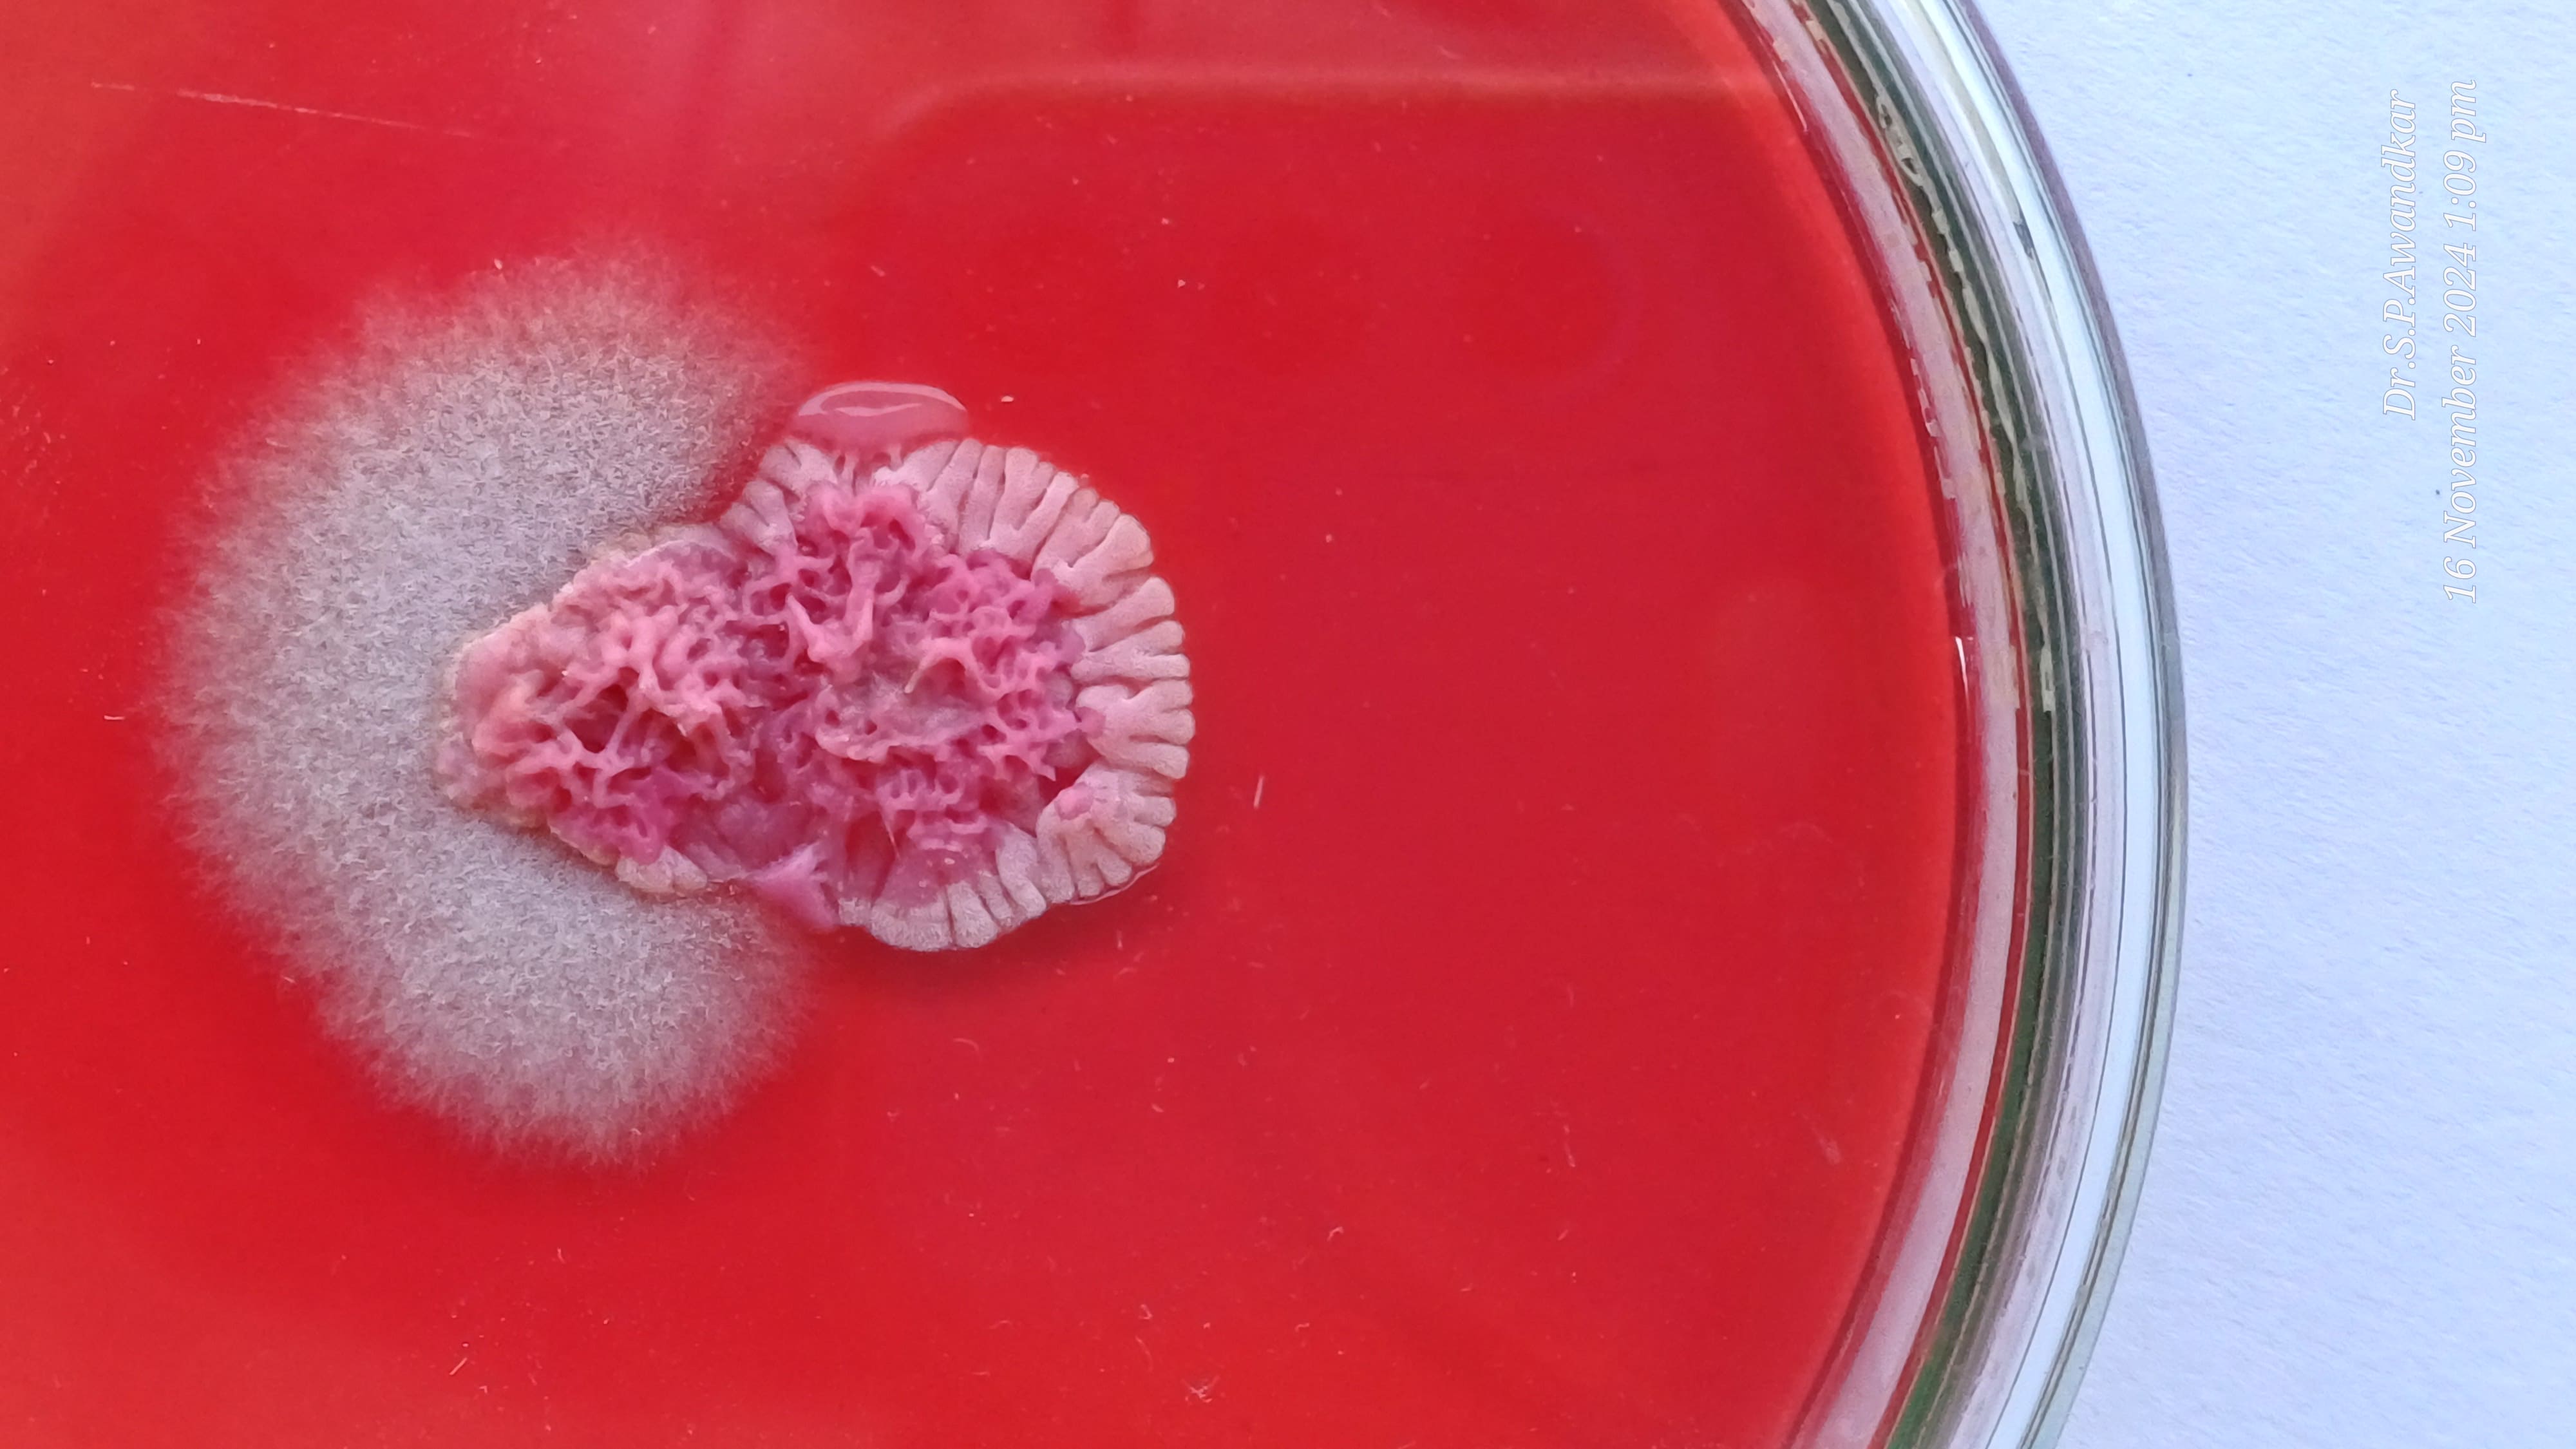
33. Trichophyton Rubrum
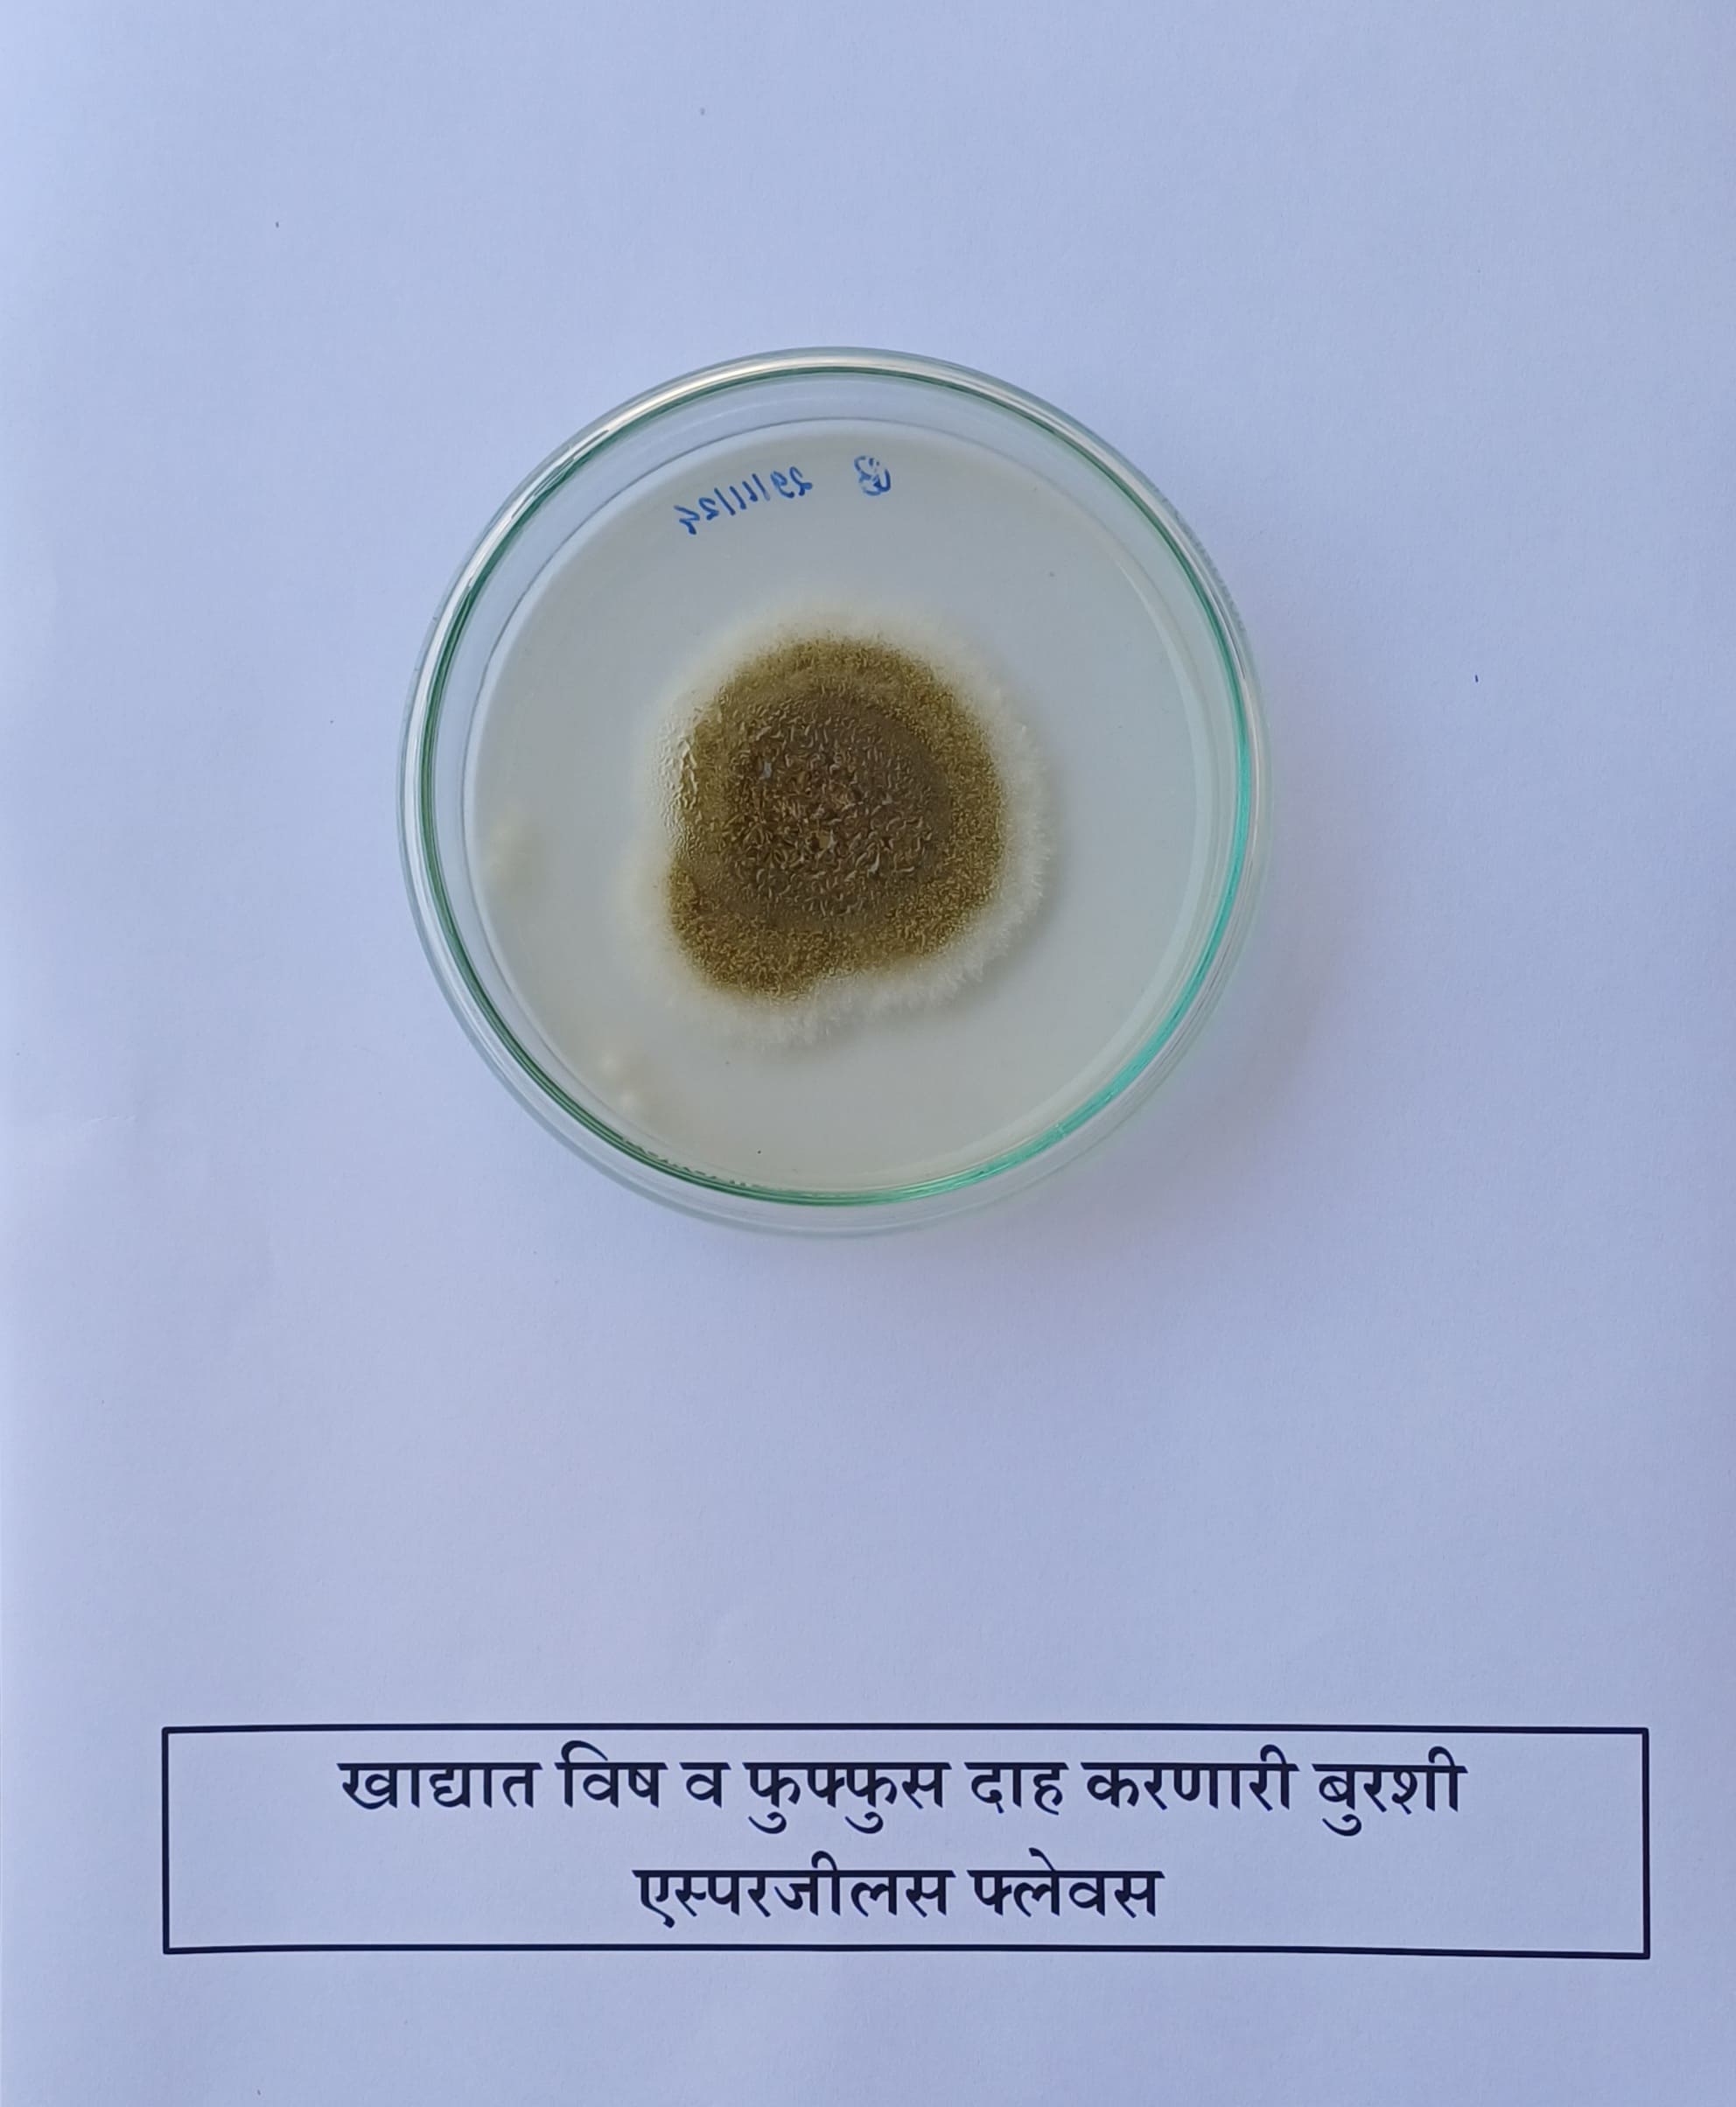
36. Aspergillus Flavus
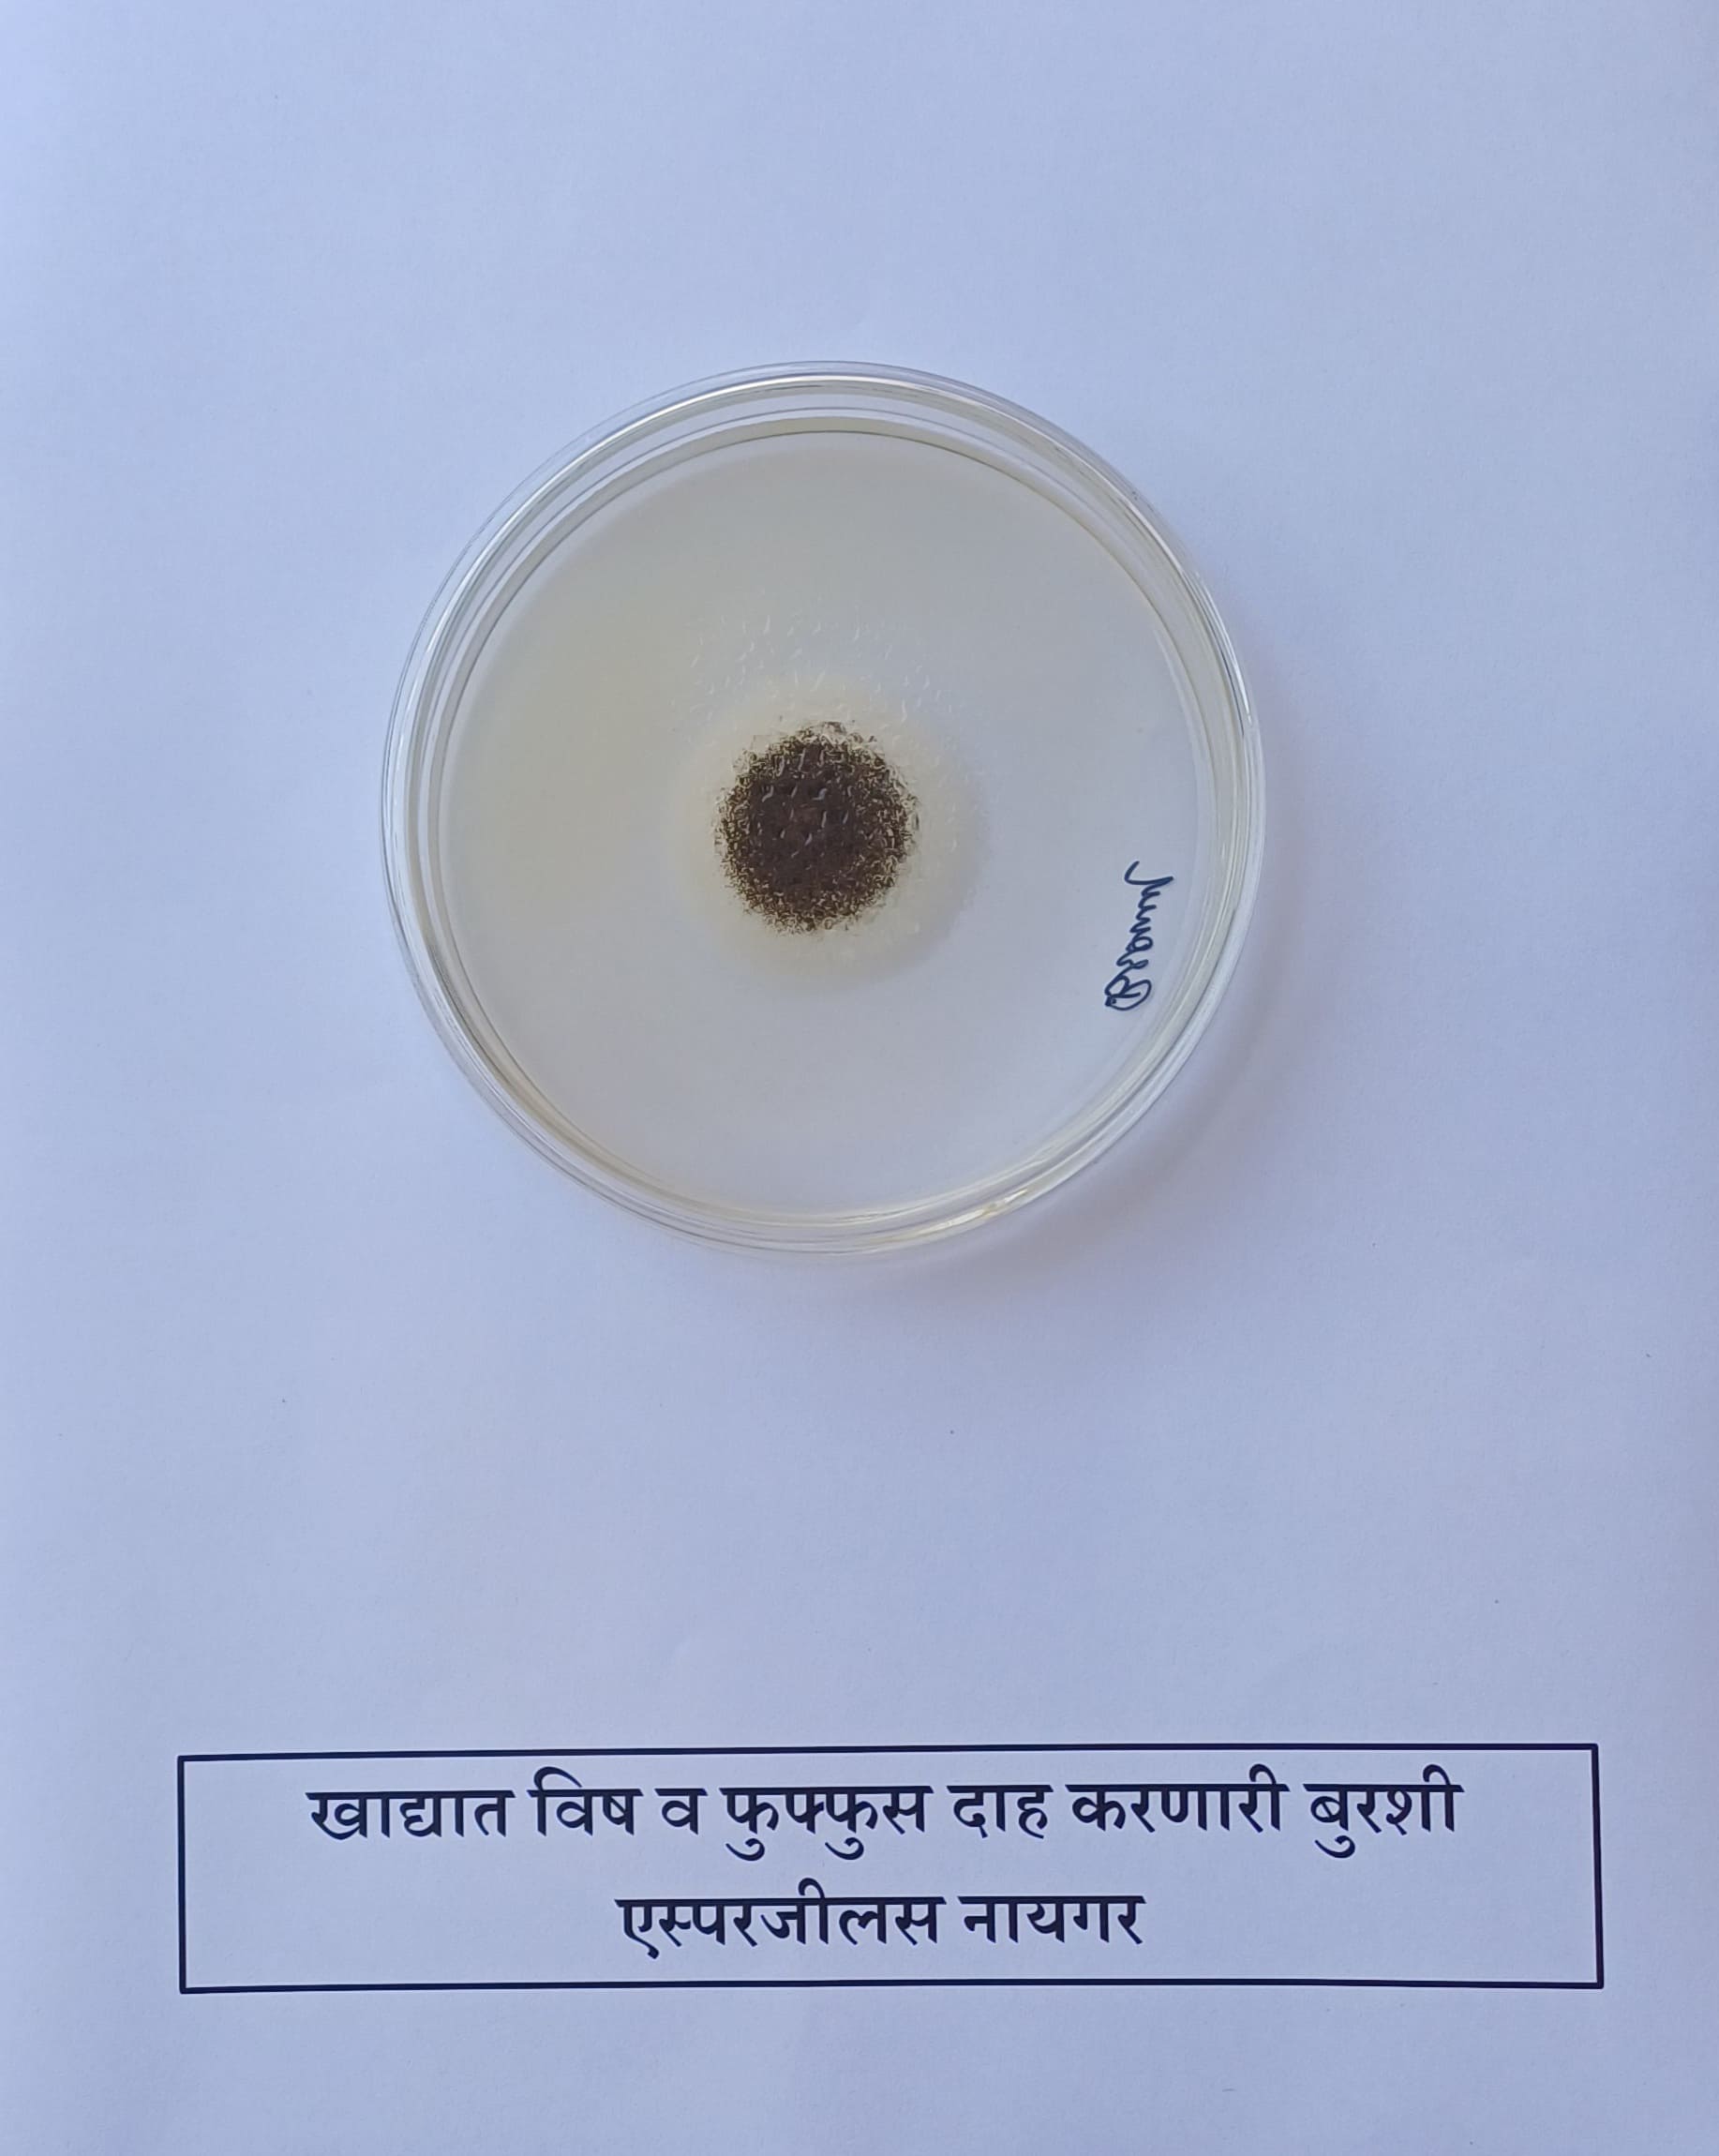
40. Aspergillus Niger
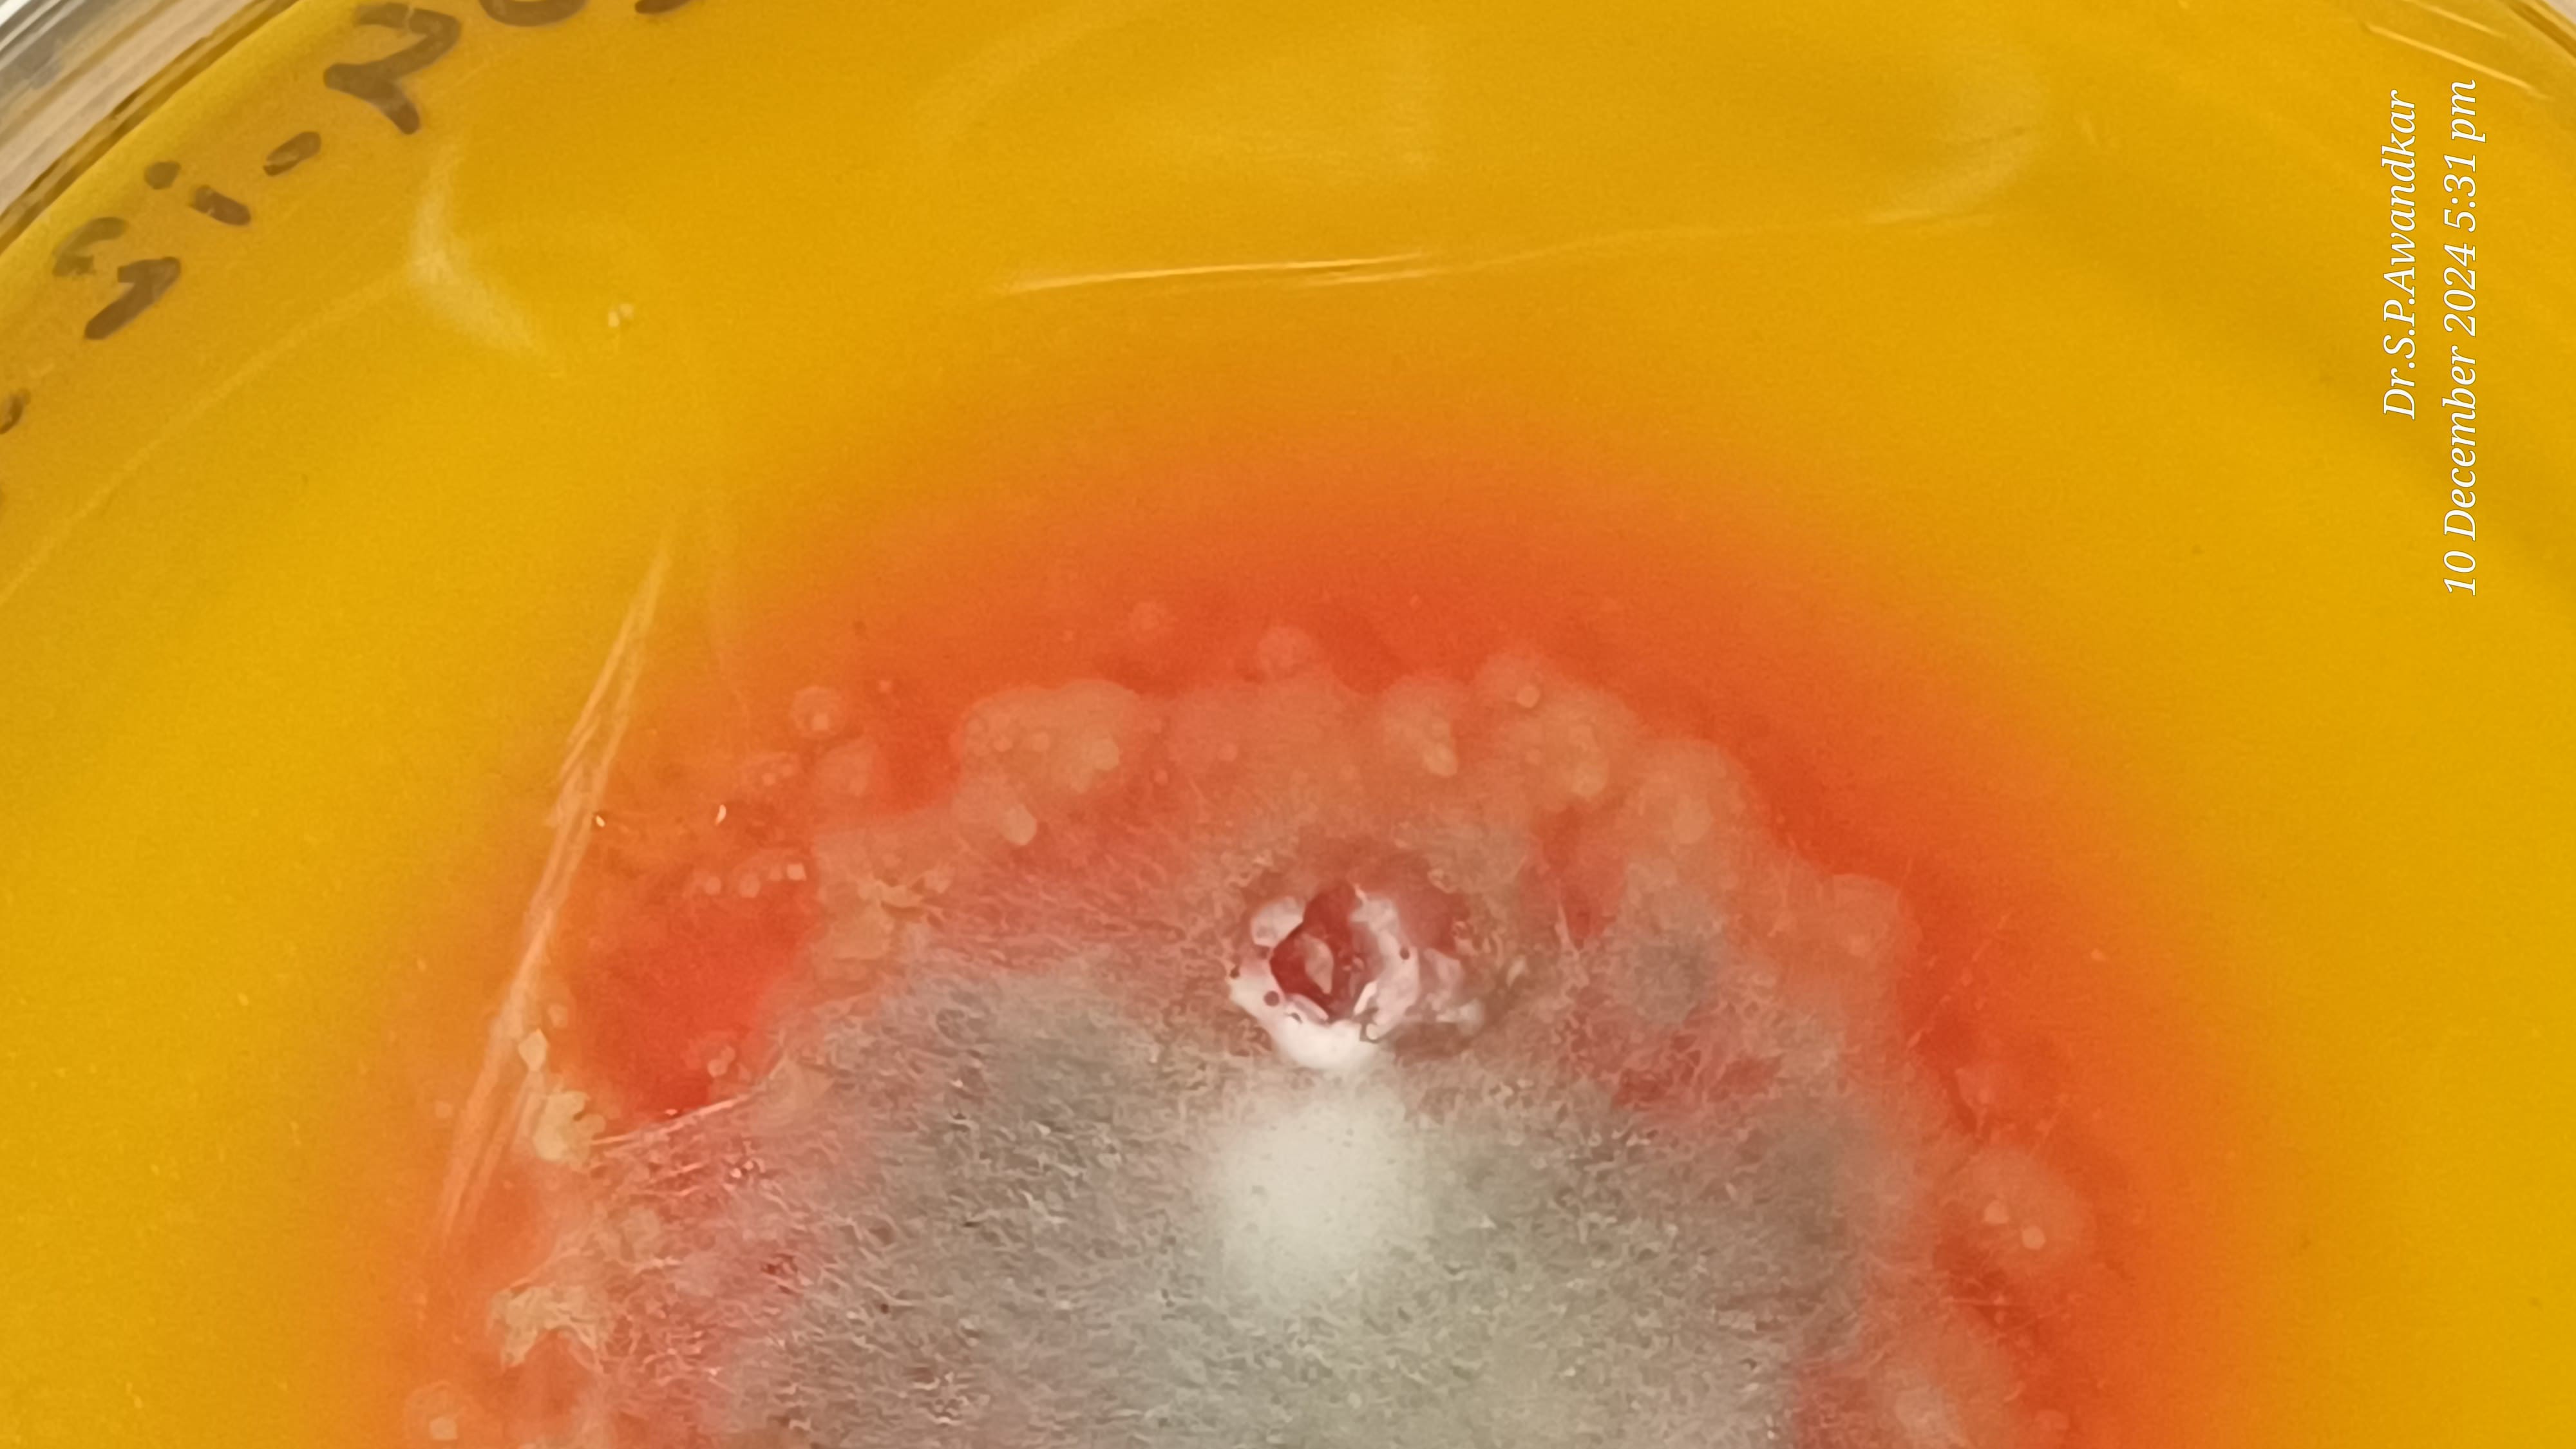
41. Basidiobolus Colony
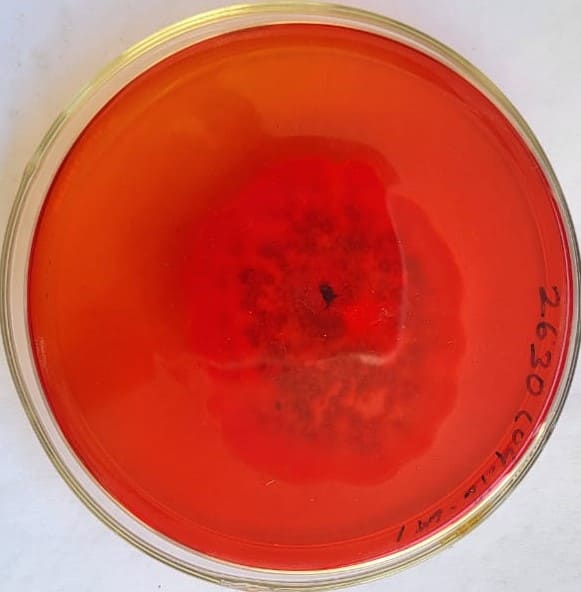
41. Basidiobolus Spp. Back Side
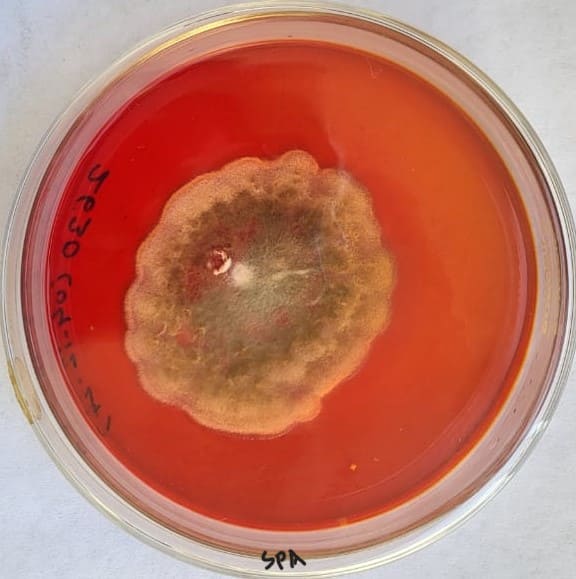
41. Basidiobolus Spp.

Scroll News
Corrigendum Walk in Interview. Click Here | Revised Notification for XII Convocation of MAFSU, Nagpur, Last date for registration 25/02/2025 Click Here | Revised notification of B.V.Sc. & A.H. degree course 2024-25 (COVAS, Akola). (English Click Here ) , ( Marathi Click Here ) | Advertisement for legal advisor to be published in University website Click Here

The Department of Veterinary Microbiology was established on 3rd January 2024 at the Post Graduate Institute of Veterinary and Animal Sciences, Akola, by repurposing the old building of the Department of Animal Reproduction and Gynecology. The department's foundation was marked by the transfer of services of Dr. S.P. Awandkar, Professor of Veterinary Microbiology, who established the department.
By the end of March 2024, the department had been strengthened through the procurement of all essential laboratory equipment. This enabled the sequential establishment of specialized laboratories:
With these laboratories operational, the department commenced technical services for microbiological investigations, contributing to revenue generation. An intramural research program titled “Isolation, Characterization, and Culture Collection of Pathogens of Veterinary and Zoonotic Importance from the Vidarbha Region” was launched from the academic year 2024–25.
In addition, the department actively engaged in extension activities targeting farmers and technocrats across the region.
A proposal for initiating a postgraduate (PG) program was submitted to the University within the department’s first year.
On 1st April 2025, the department was conglomerated to the newly established College of Veterinary and Animal Sciences, Akola, further marking a new chapter in its development.
| Bacteriology | Mycology | Immunology | Virology & Cell Culture | Microbial Biotechnology |
|---|---|---|---|---|
| BSL-II Cabinet | Yeasts and Molds isolation facility | Haemagglutination Assays | Laminar Air Flow | DNA Extraction |
| BOD Incubator | Yeasts and Molds identification facility | Haemagglutination Inhibition Assays | Inverted Microscope | RNA Extraction |
| Bacteriological Incubator | KOH Mount | Plate Agglutination tests for brucellosis and Salmonellosis | Research Microscopes | cDNA Preparation |
| Centrifuge | LCB Mount | Tube Agglutination test | Weighing Balance | Gradient PCR |
| Microscopes | Microscopes | Latex Agglutination test | Magnetic Stirrer | Agar Gel Electrophoresis |
| Bacterial isolation facility | Antifungal Sensitivity Testing | Precipitation Assays | Vortex Mixer | Poly Acrylamide Gel Electrophoresis |
| Bacterial identification facility | Dermatophyte isolation facility | Indirect ELISA | Ultra filtration systems | Gel Documentation System |
| Antibiotic Sensitivity Testing | Detection of Mycotoxins | Sandwich ELISA | Cell culture Media & Reagents | Blotting Assays |
| Colony Counter for TVC, TBC, TAC, TCC etc. | Avidin Biotin ELISA | Egg Candlers | Molecular Identification of Pathogens | |
| Anaerobic cultivation | Immuno Electrophoresis | LN2 Containers | Bioinformatics tools | |
| Calorimetry | Water Bath | CO2 Incubator | Micro pipettes | |
| Autoclaves | Chromatography | Facility for Cell Culture | Refrigerated Centrifuge | |
| Hot Air Oven | Multi-channel pipette | High Speed Centrifuge | ||
| MIC Assay | Anti Viral Assays | Water Bath | ||
| MBC Assay | Cell-Virus Interaction Assays |
Professor and Head
Department of Veterinary Microbiology
College of Veterinary and Animal Sciences (COVAS) Akola
Krishinagar, Murtijapur Road, Akola- 444104
sudhakarawandkar@mafsu.ac.in
drspawandkar@gmail.com
9503397929
View Location On Map

.jpg)

.jpg)

.jpg)

.jpg)
.jpg)
.jpg)

.jpg)

.jpg)






























